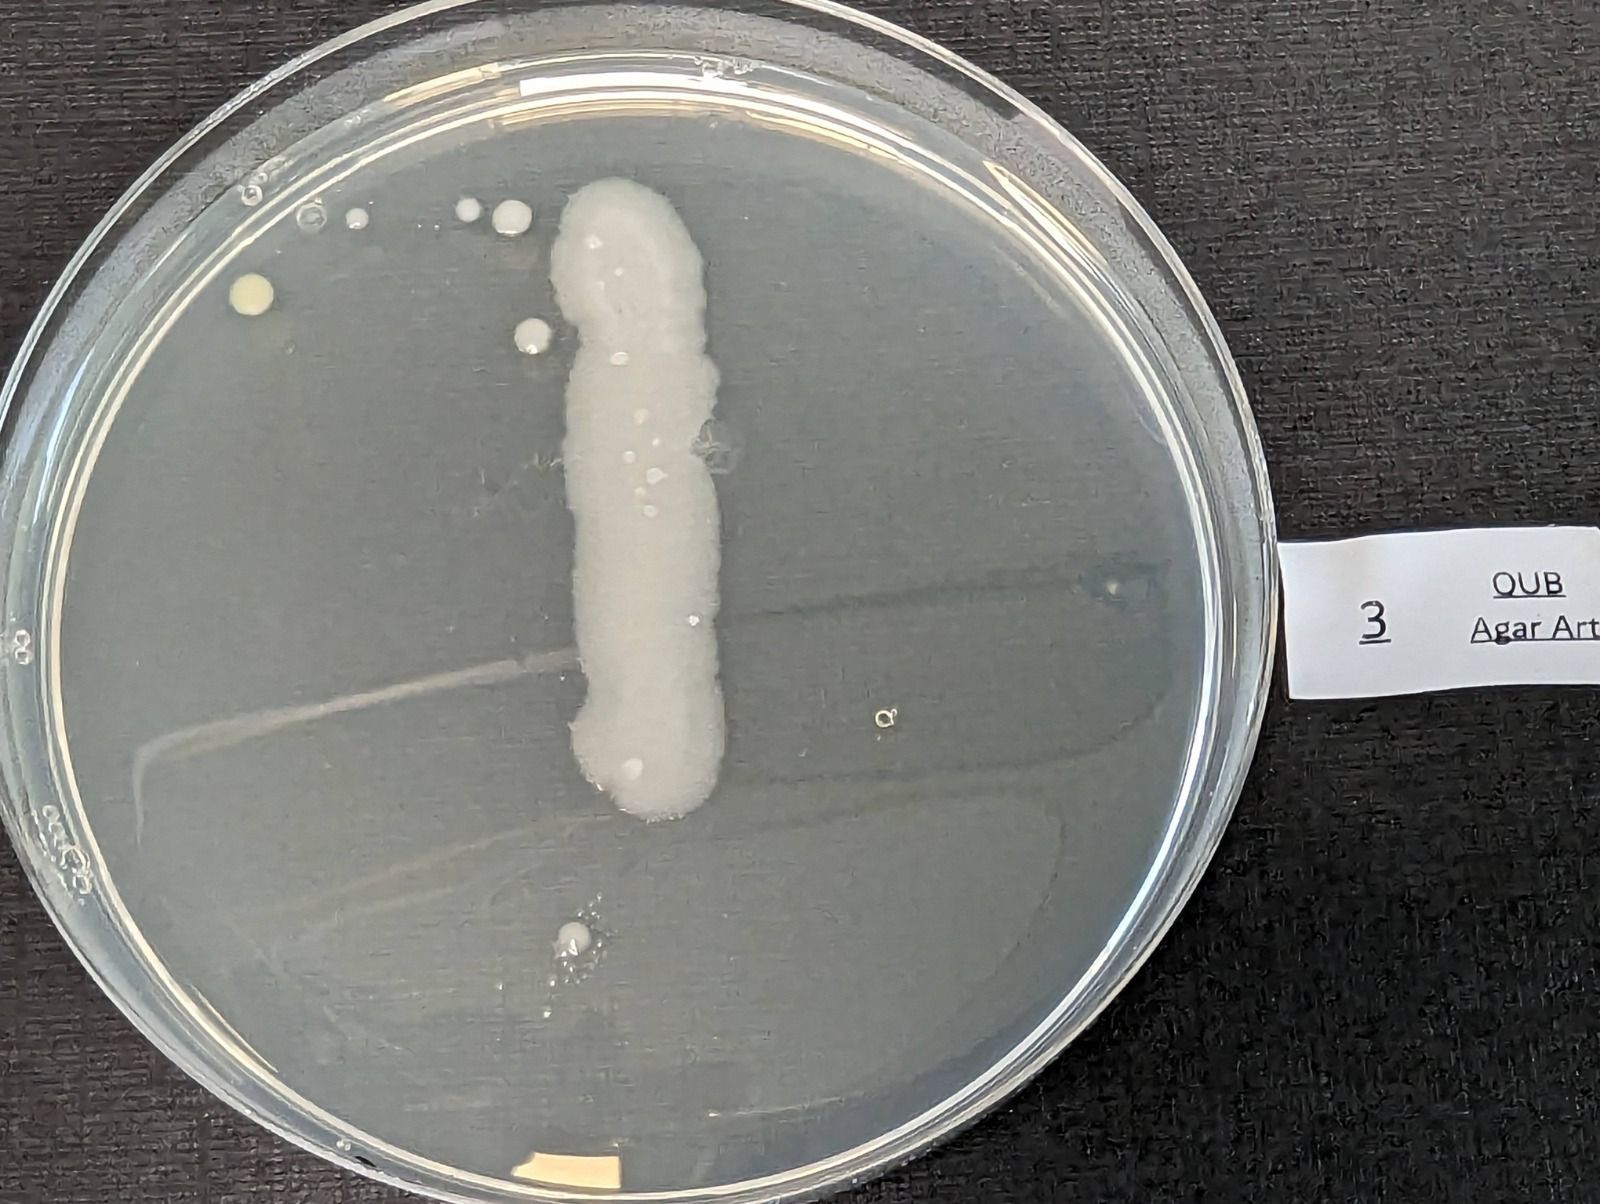
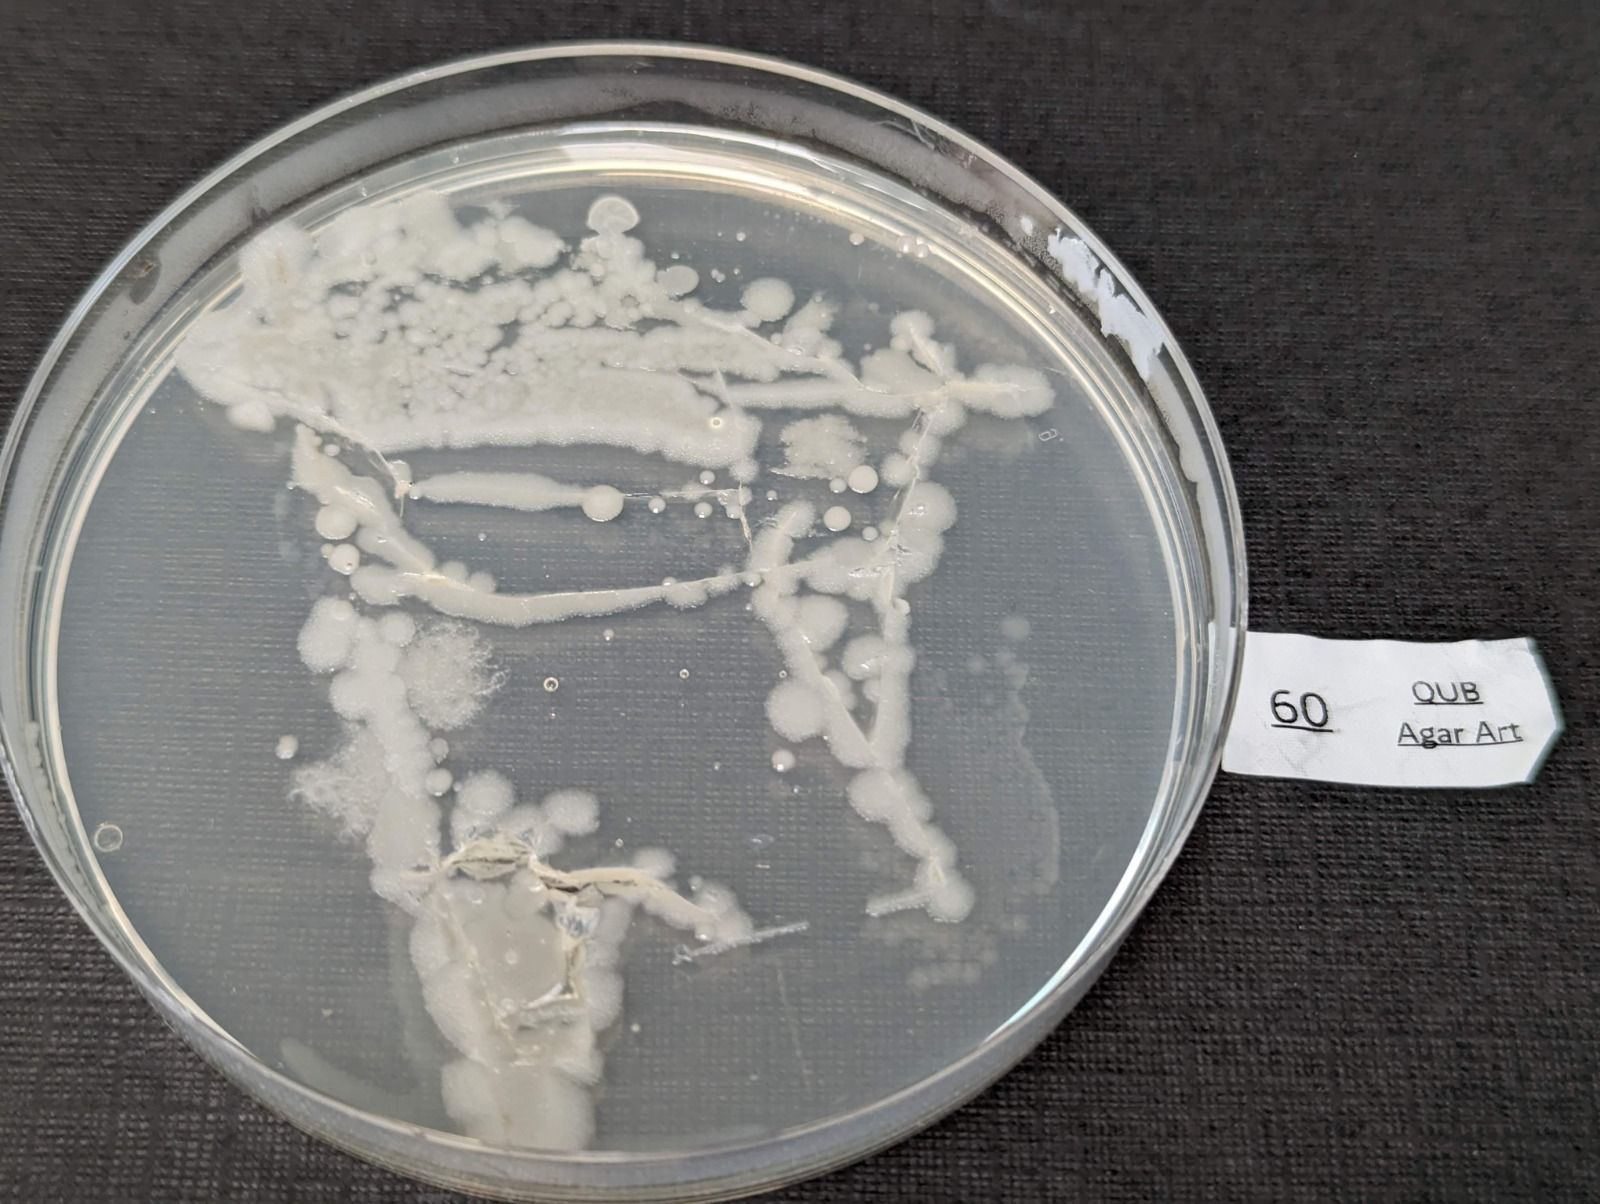
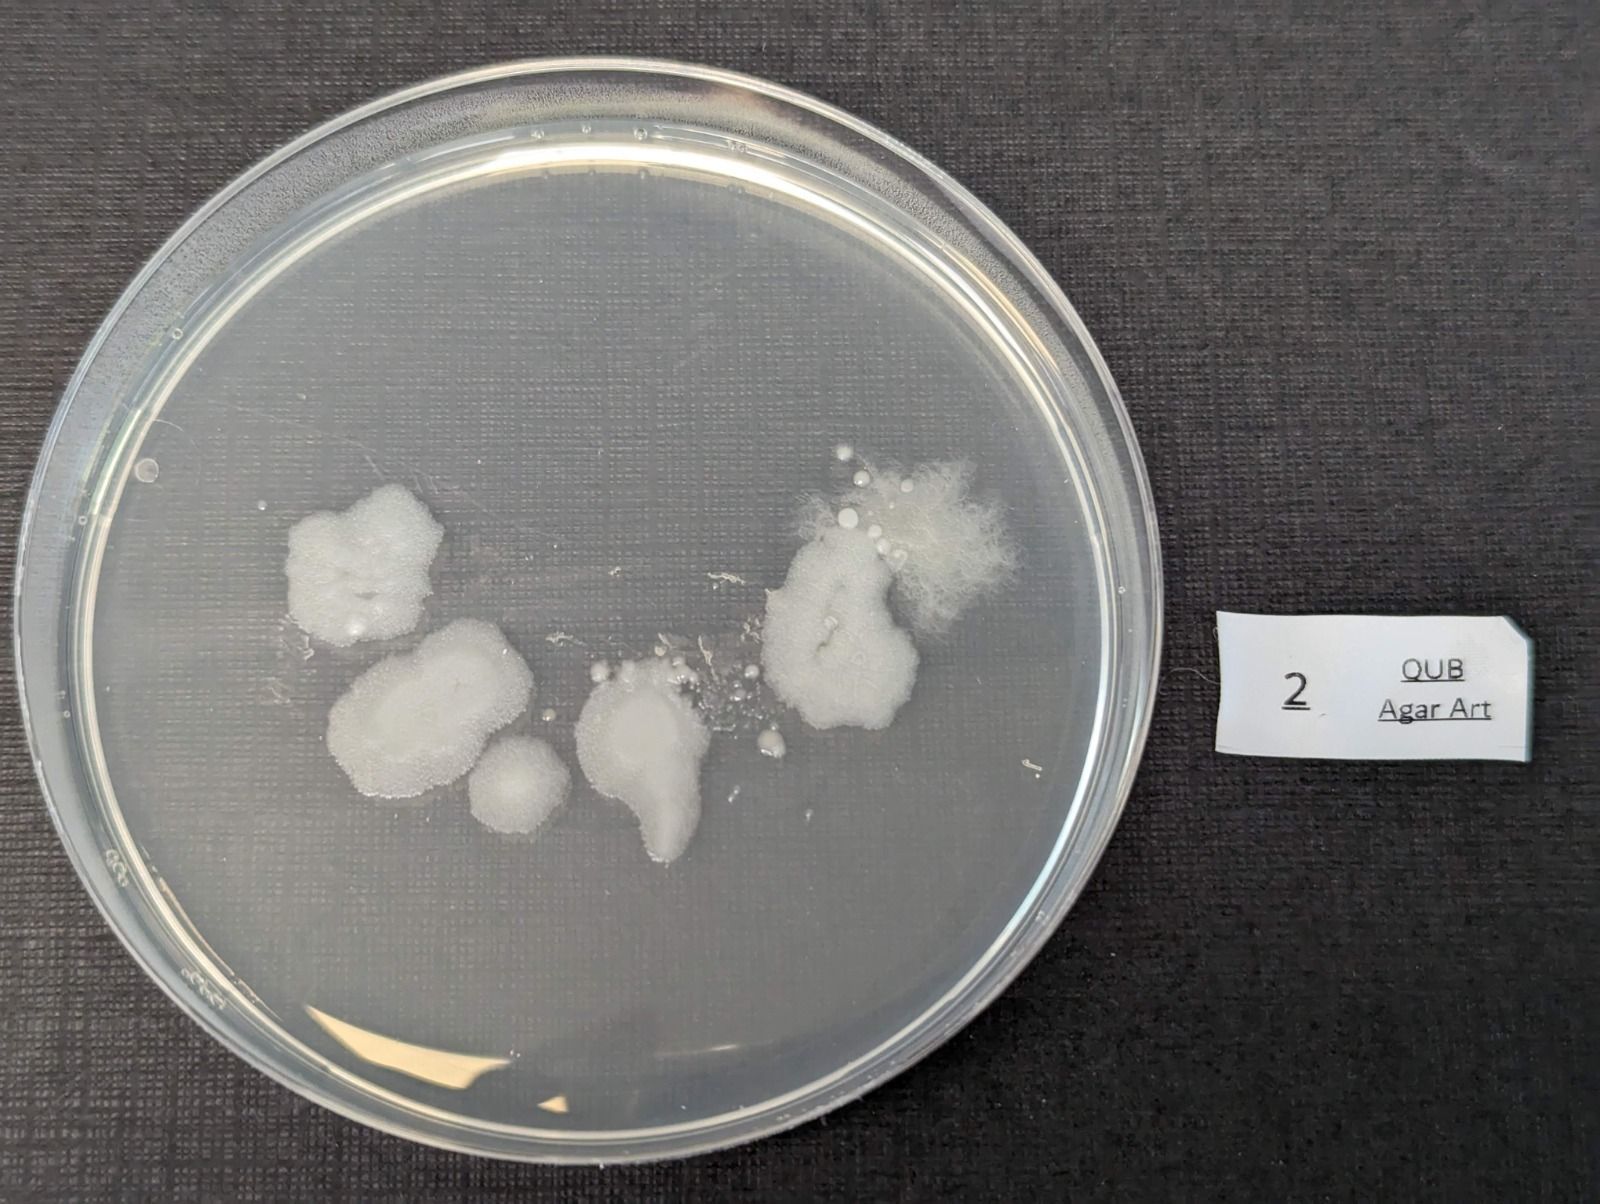
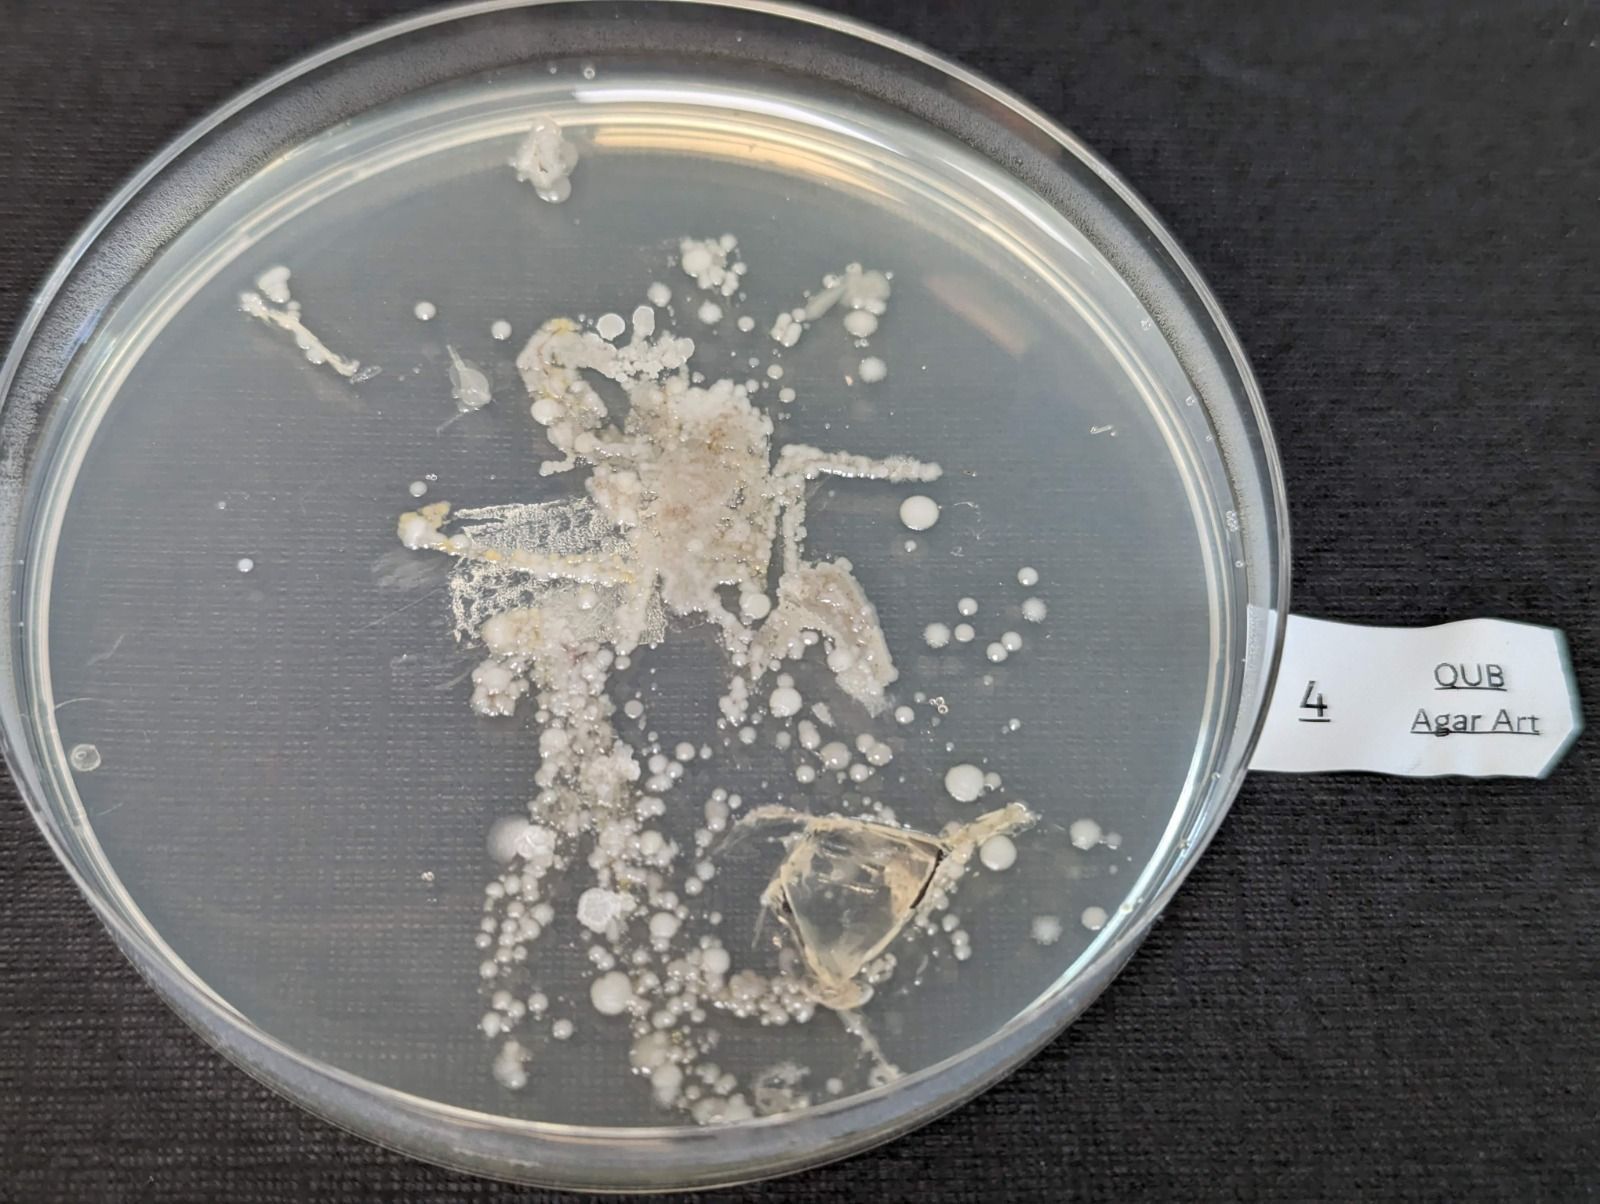
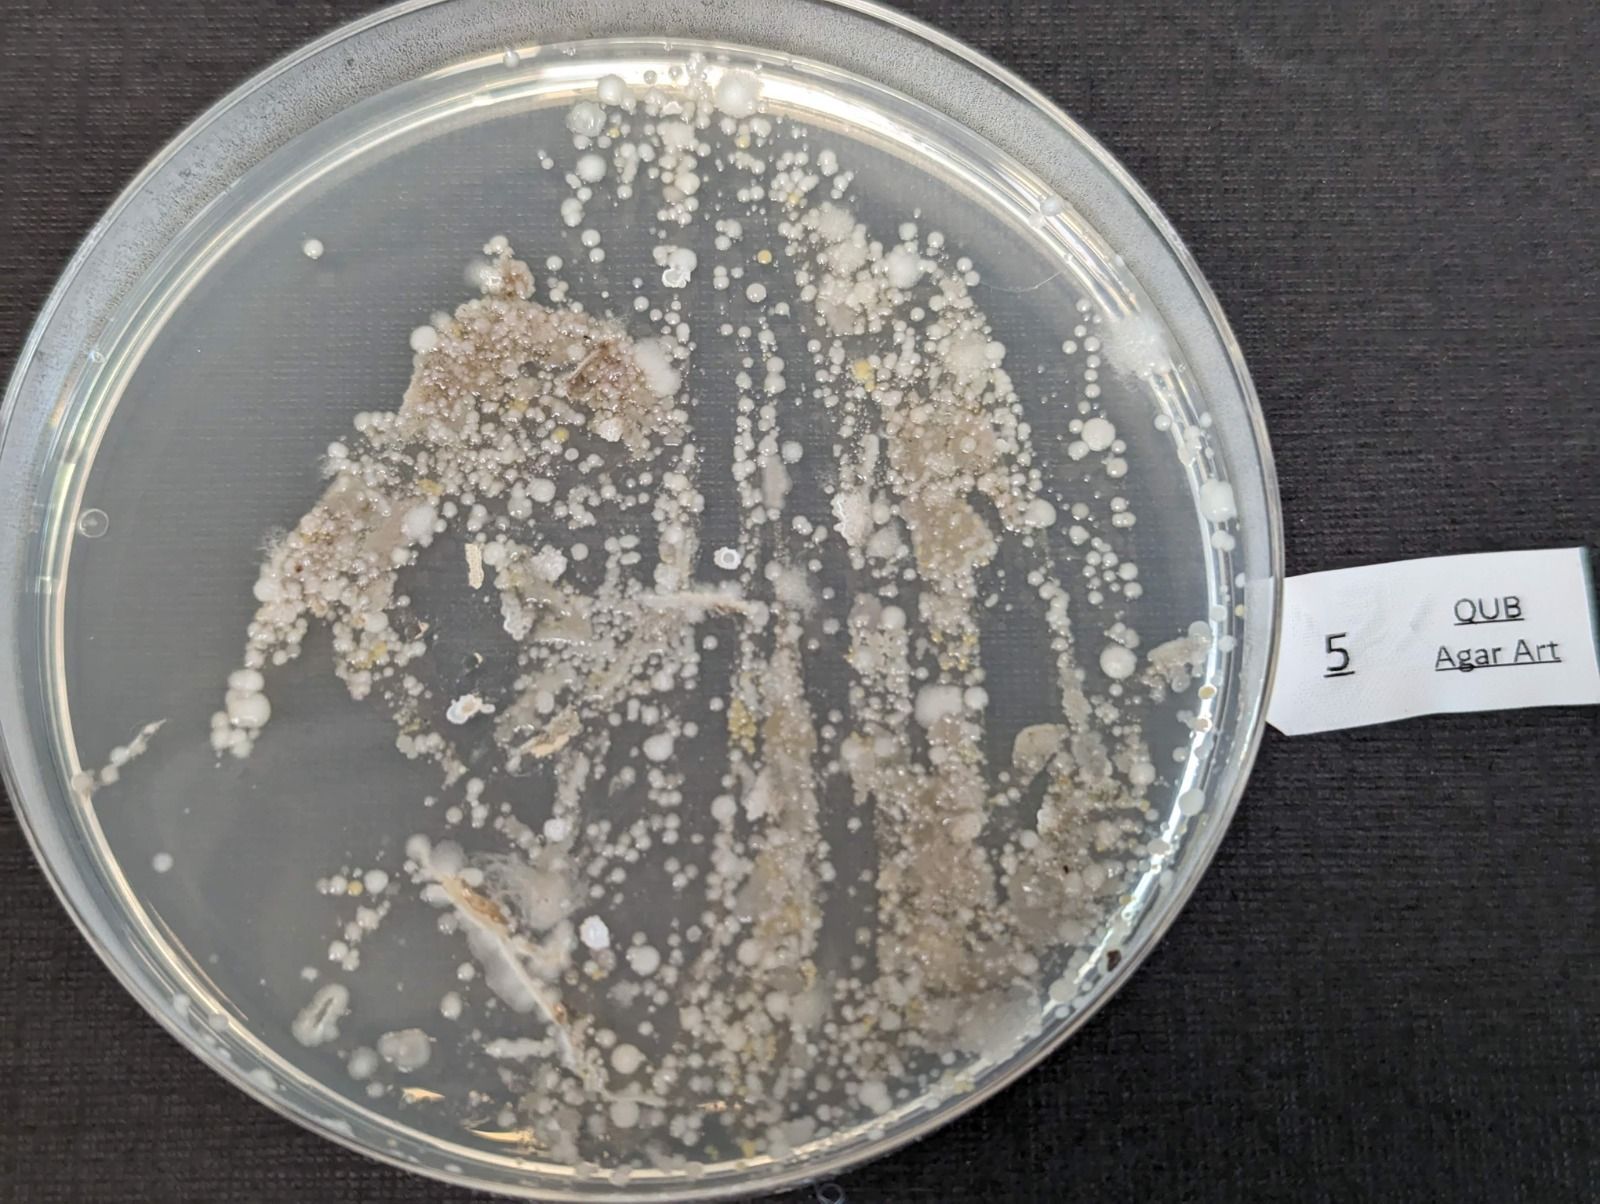
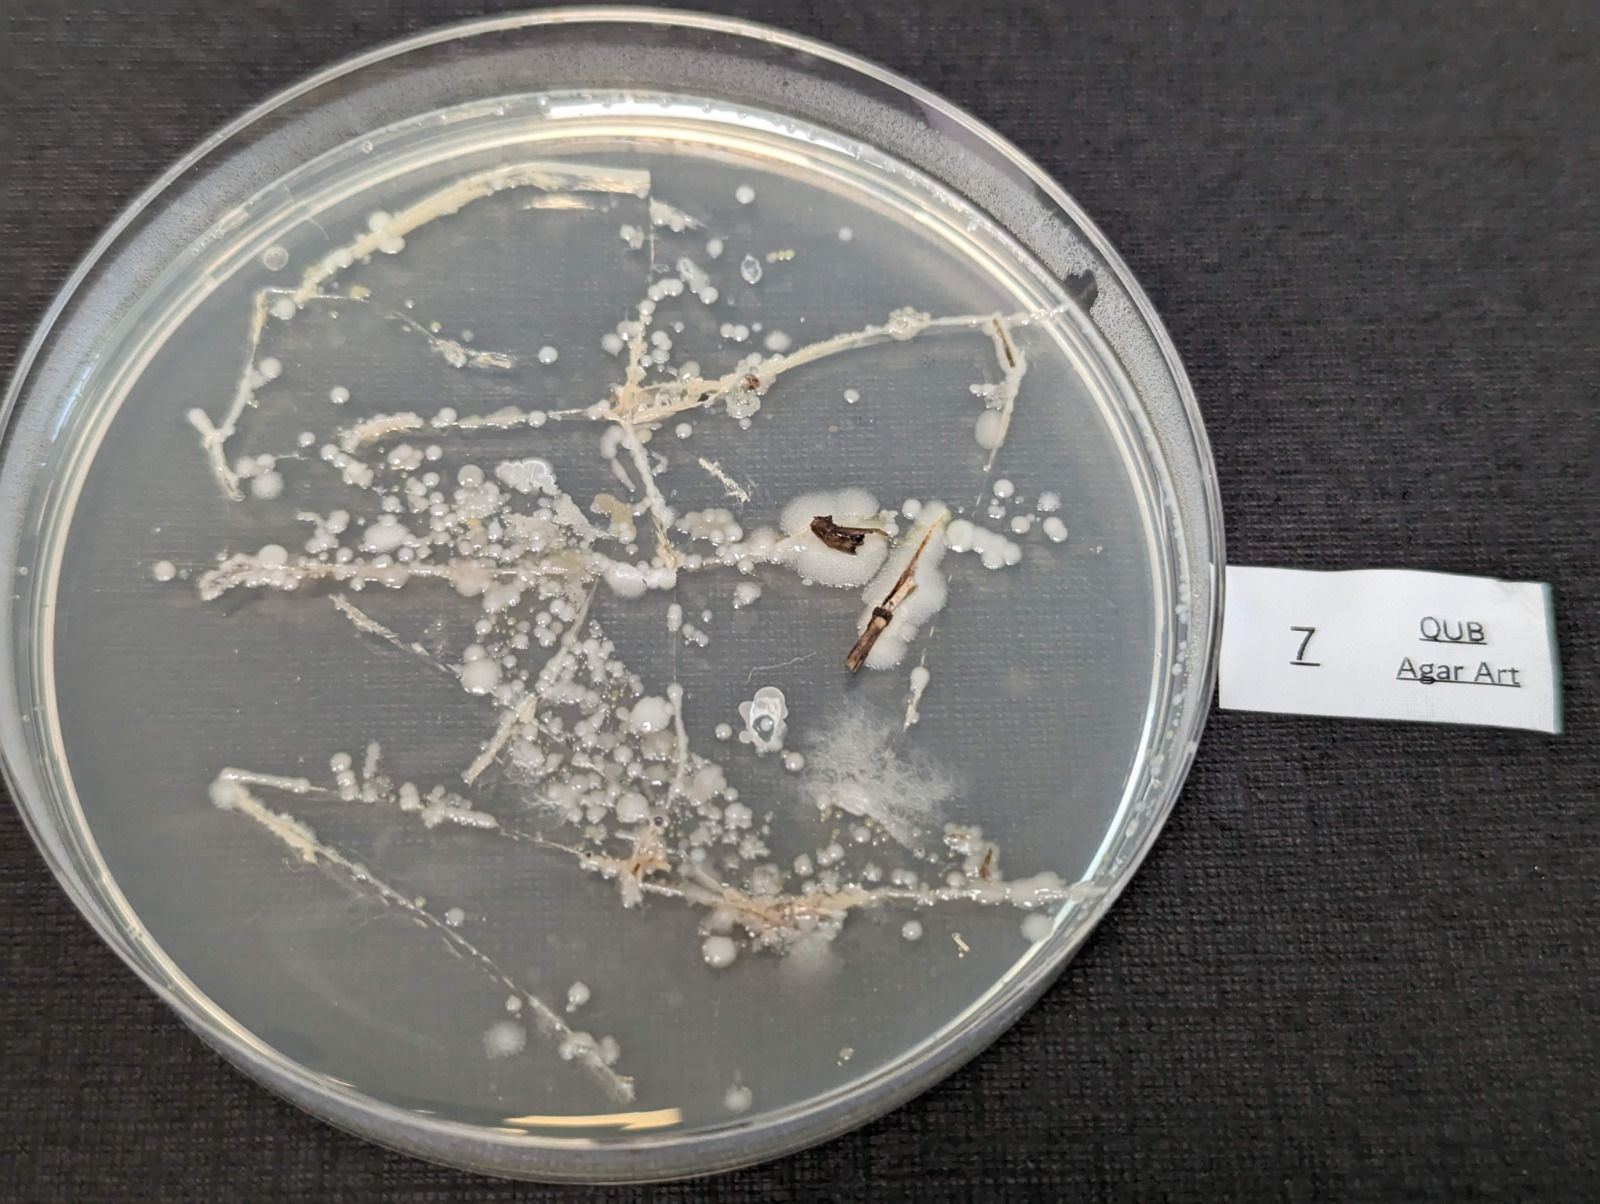
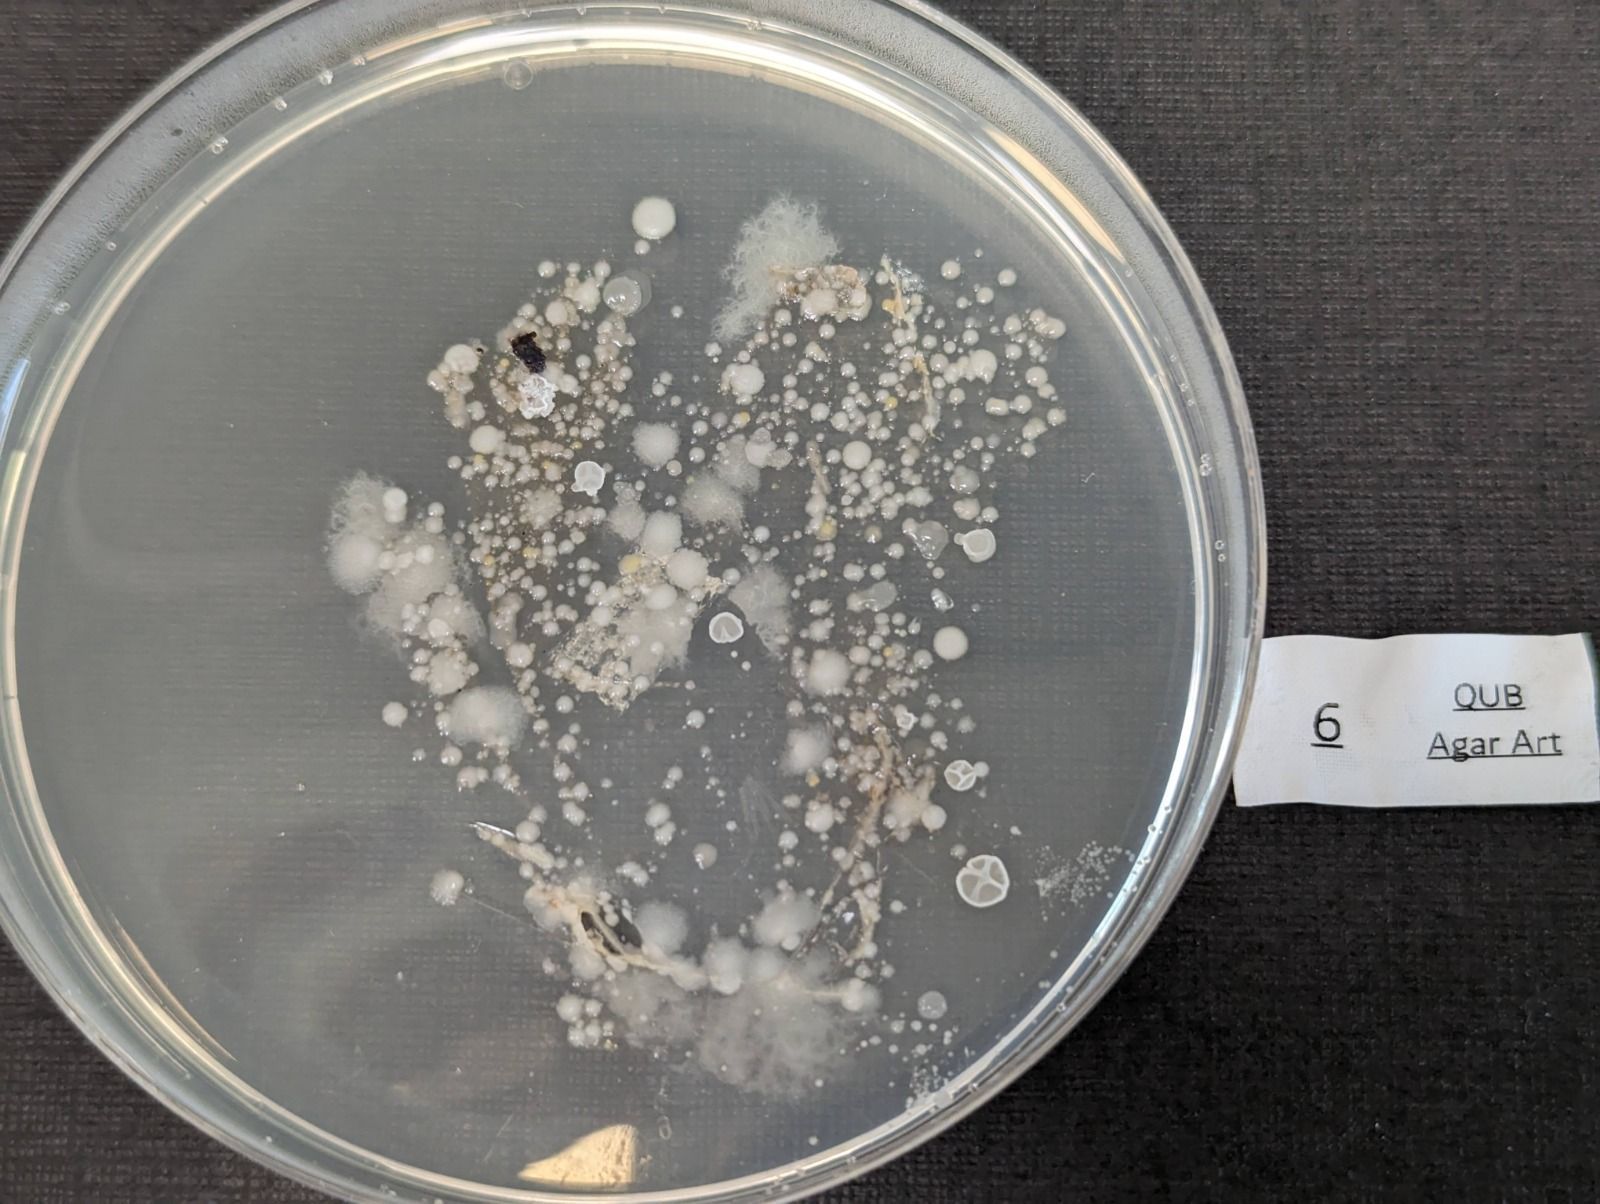
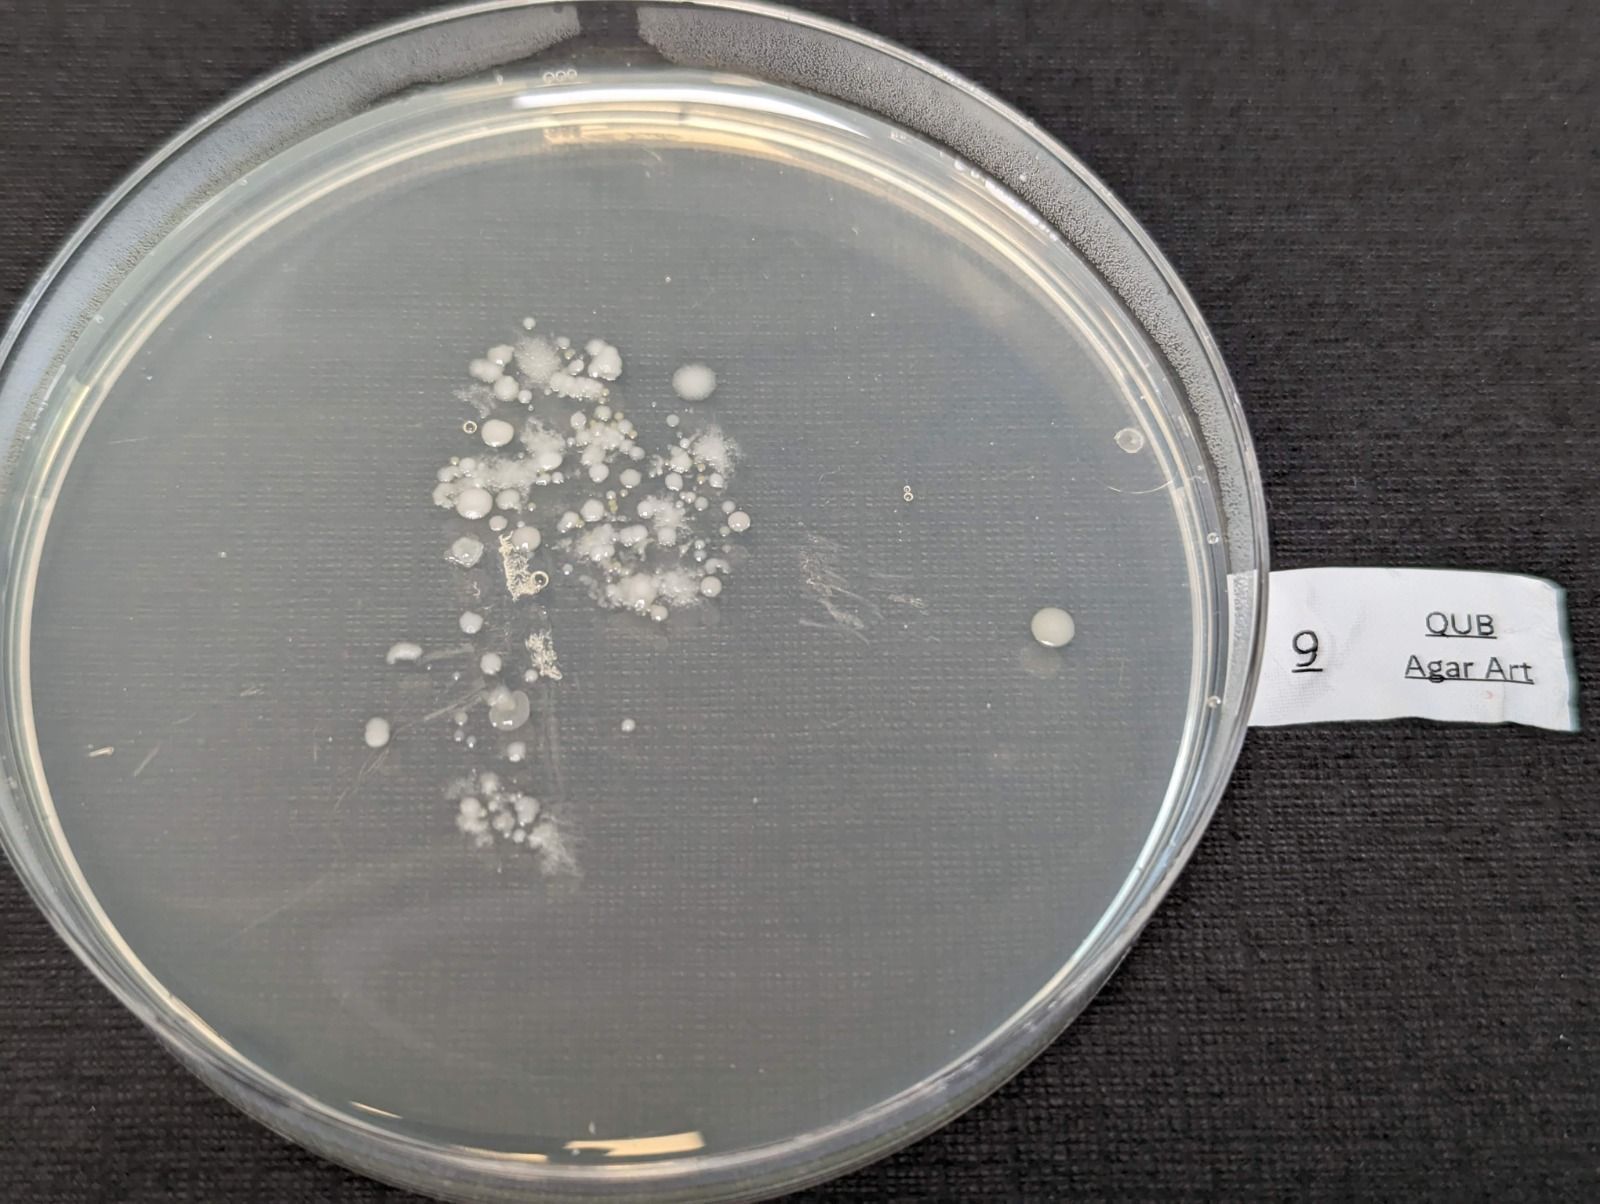
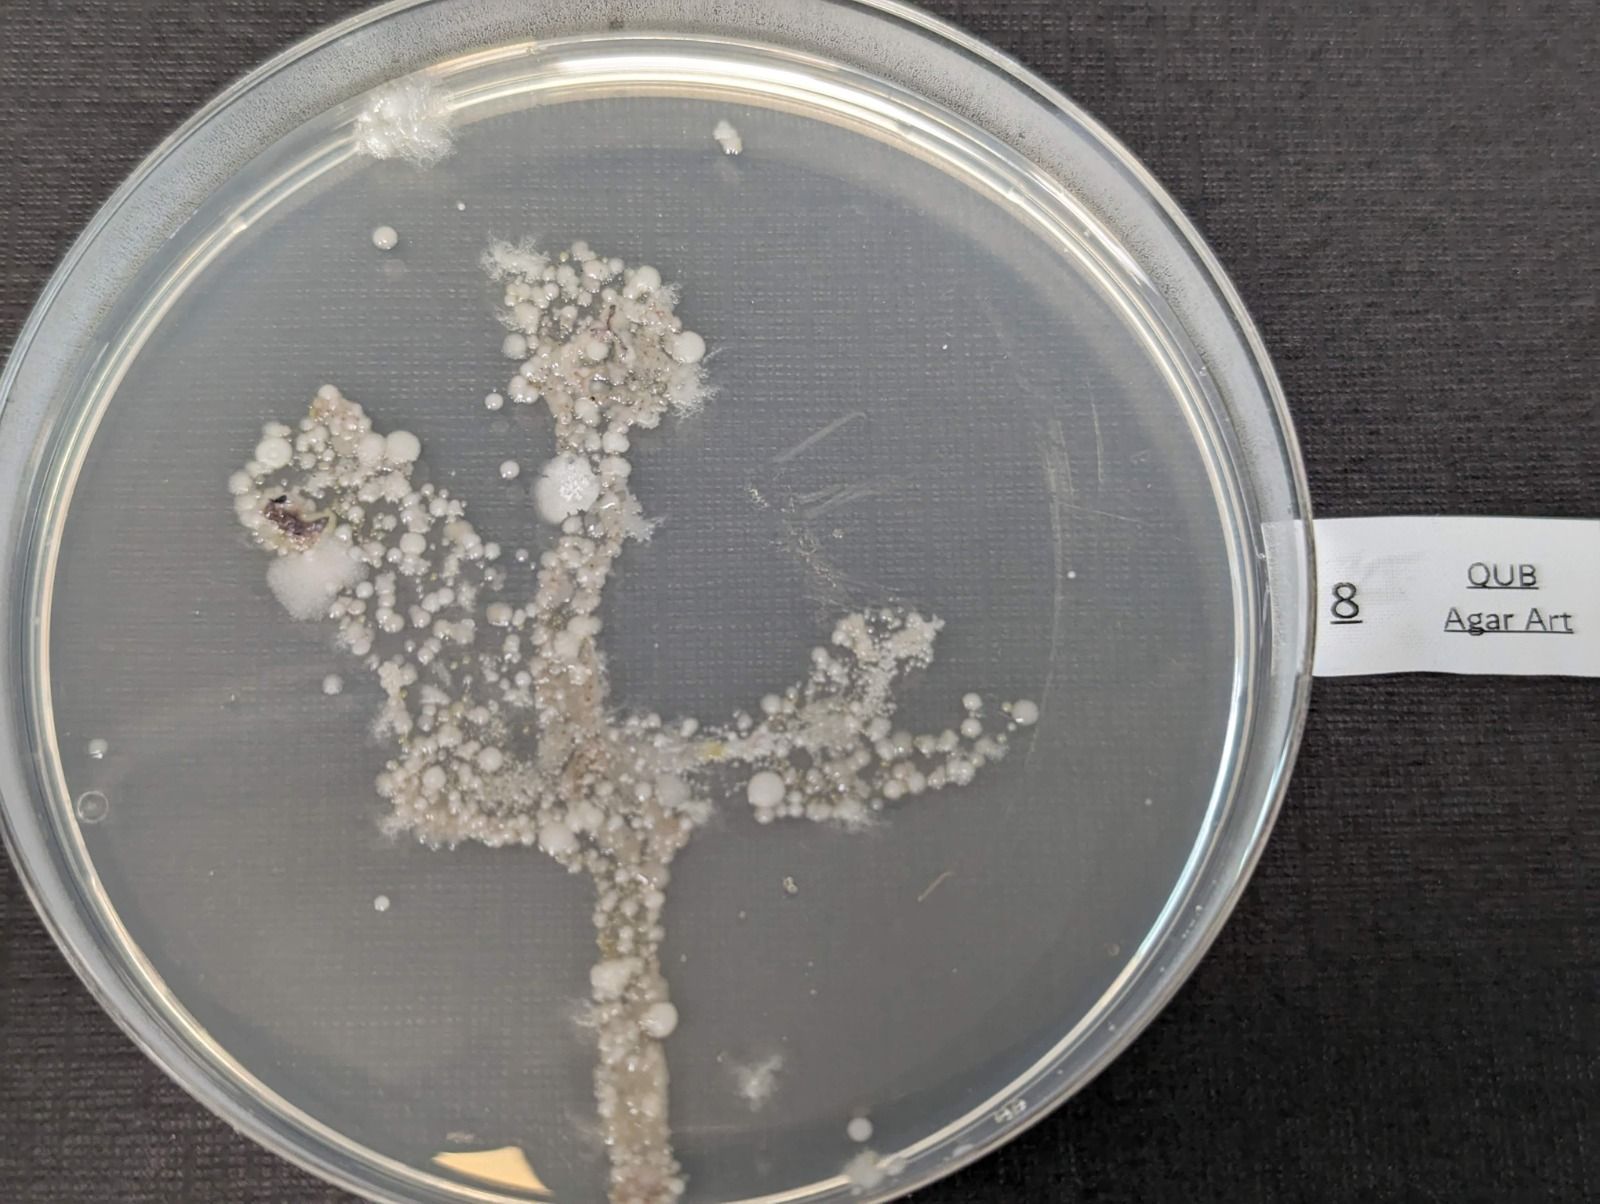
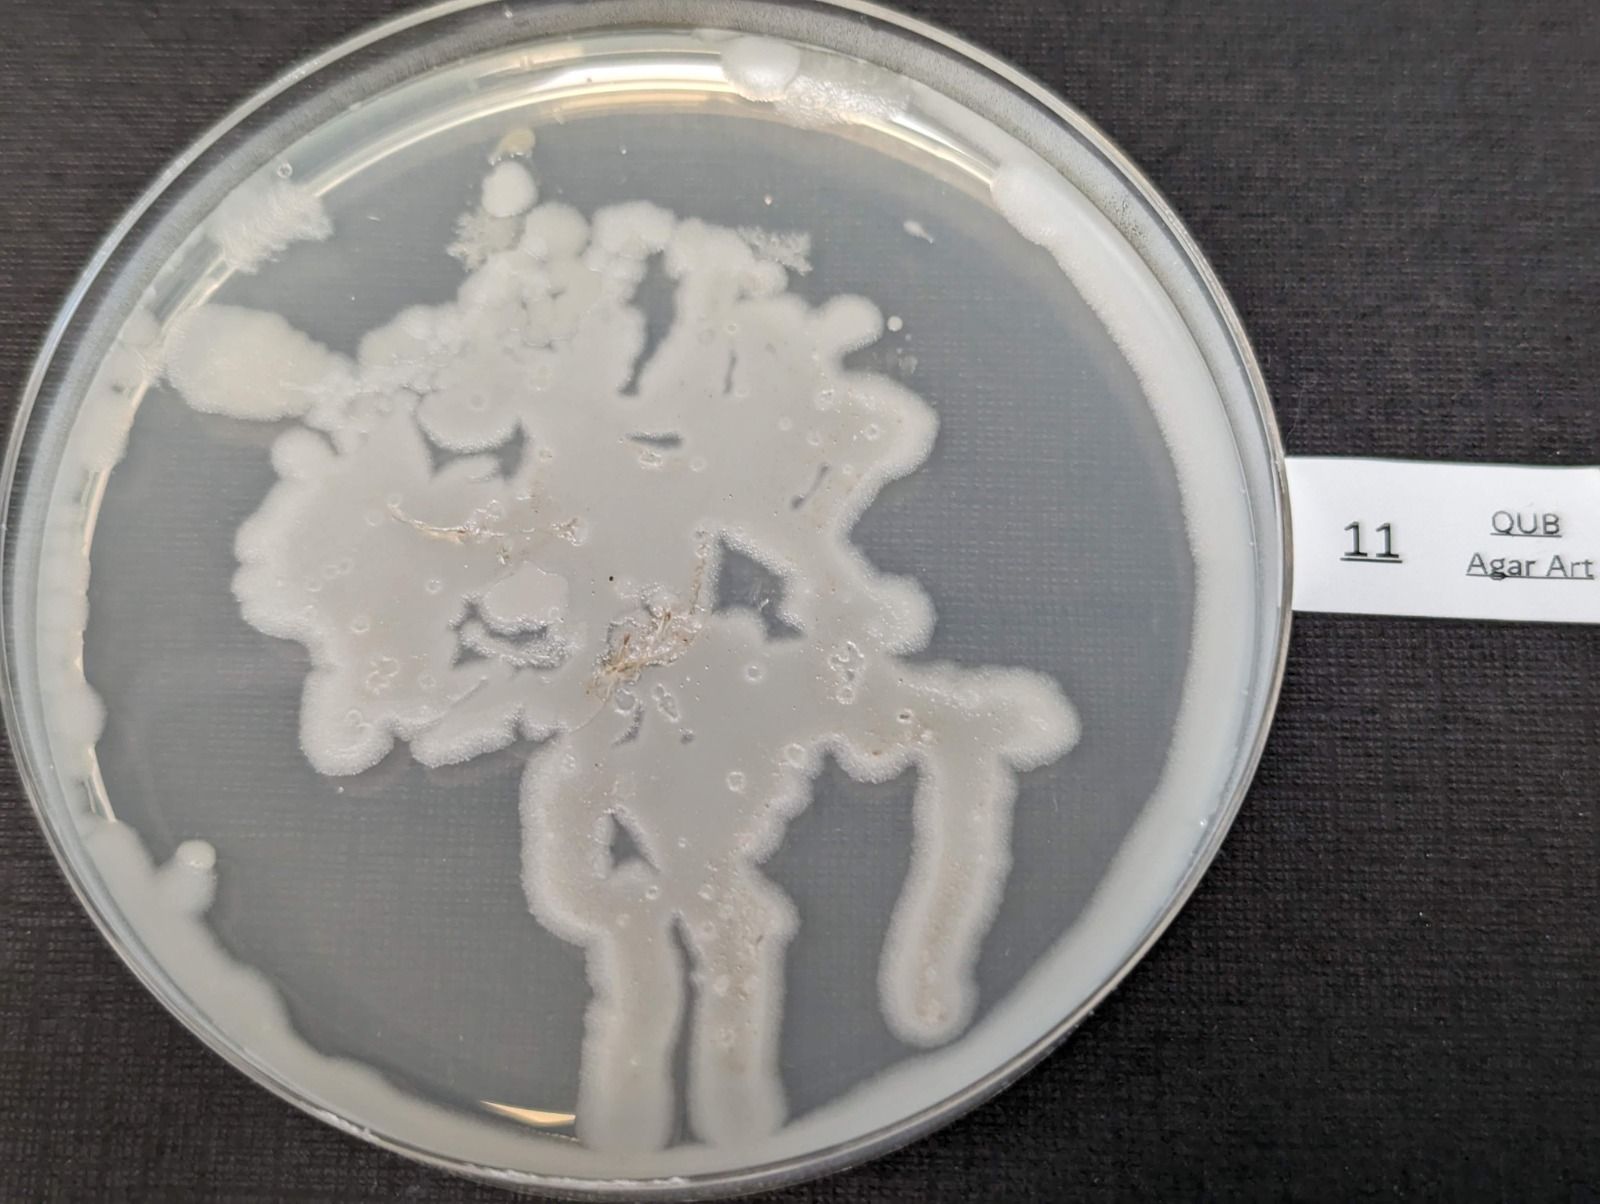
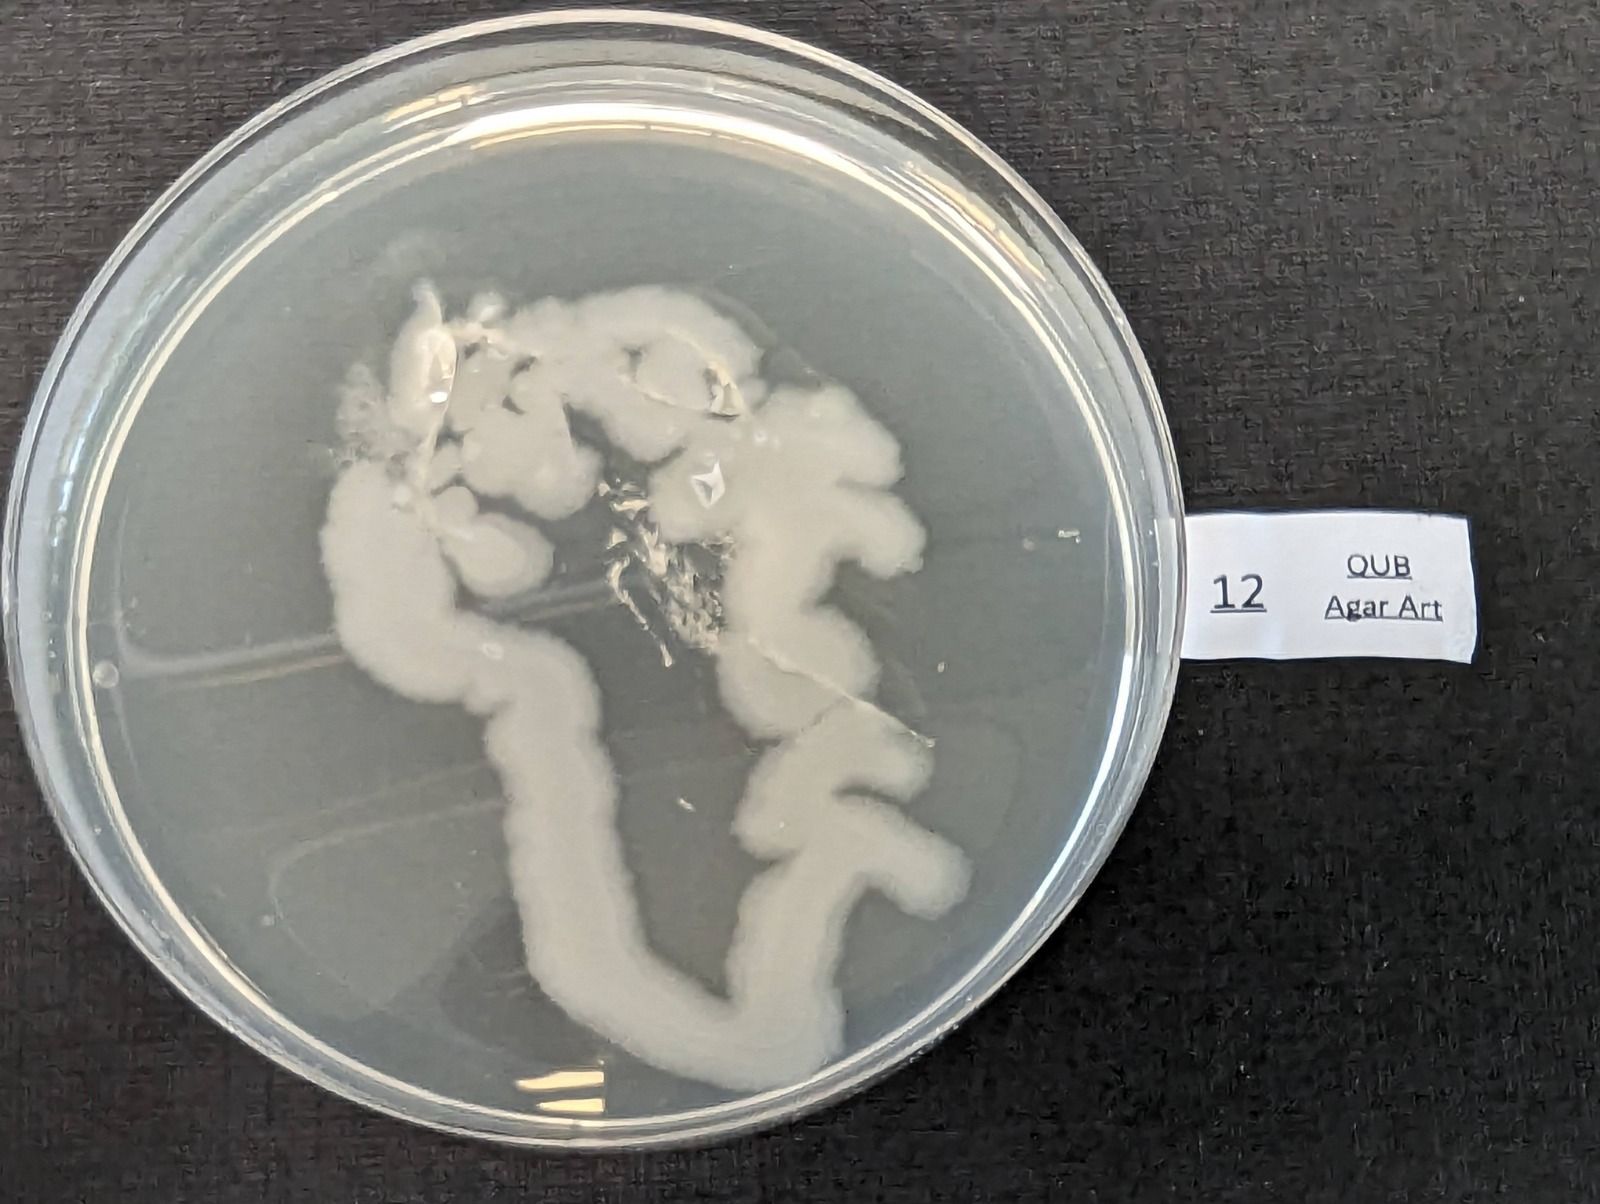
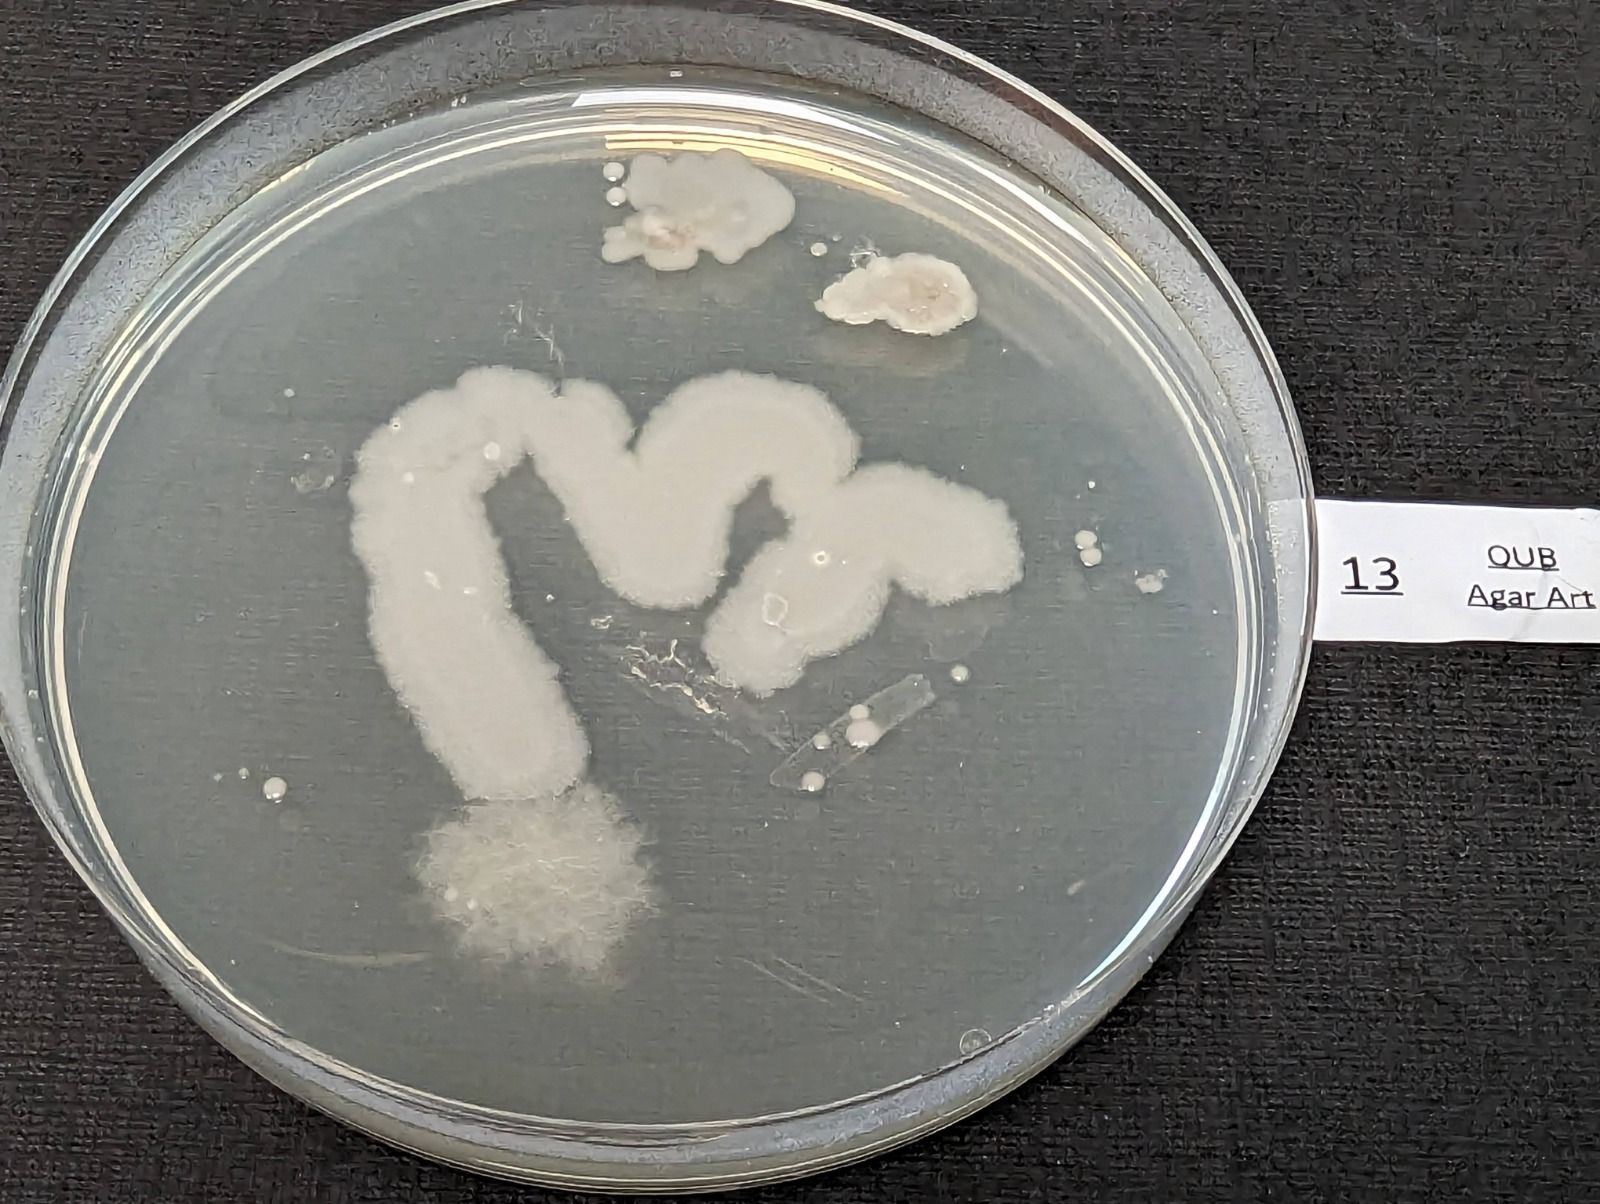
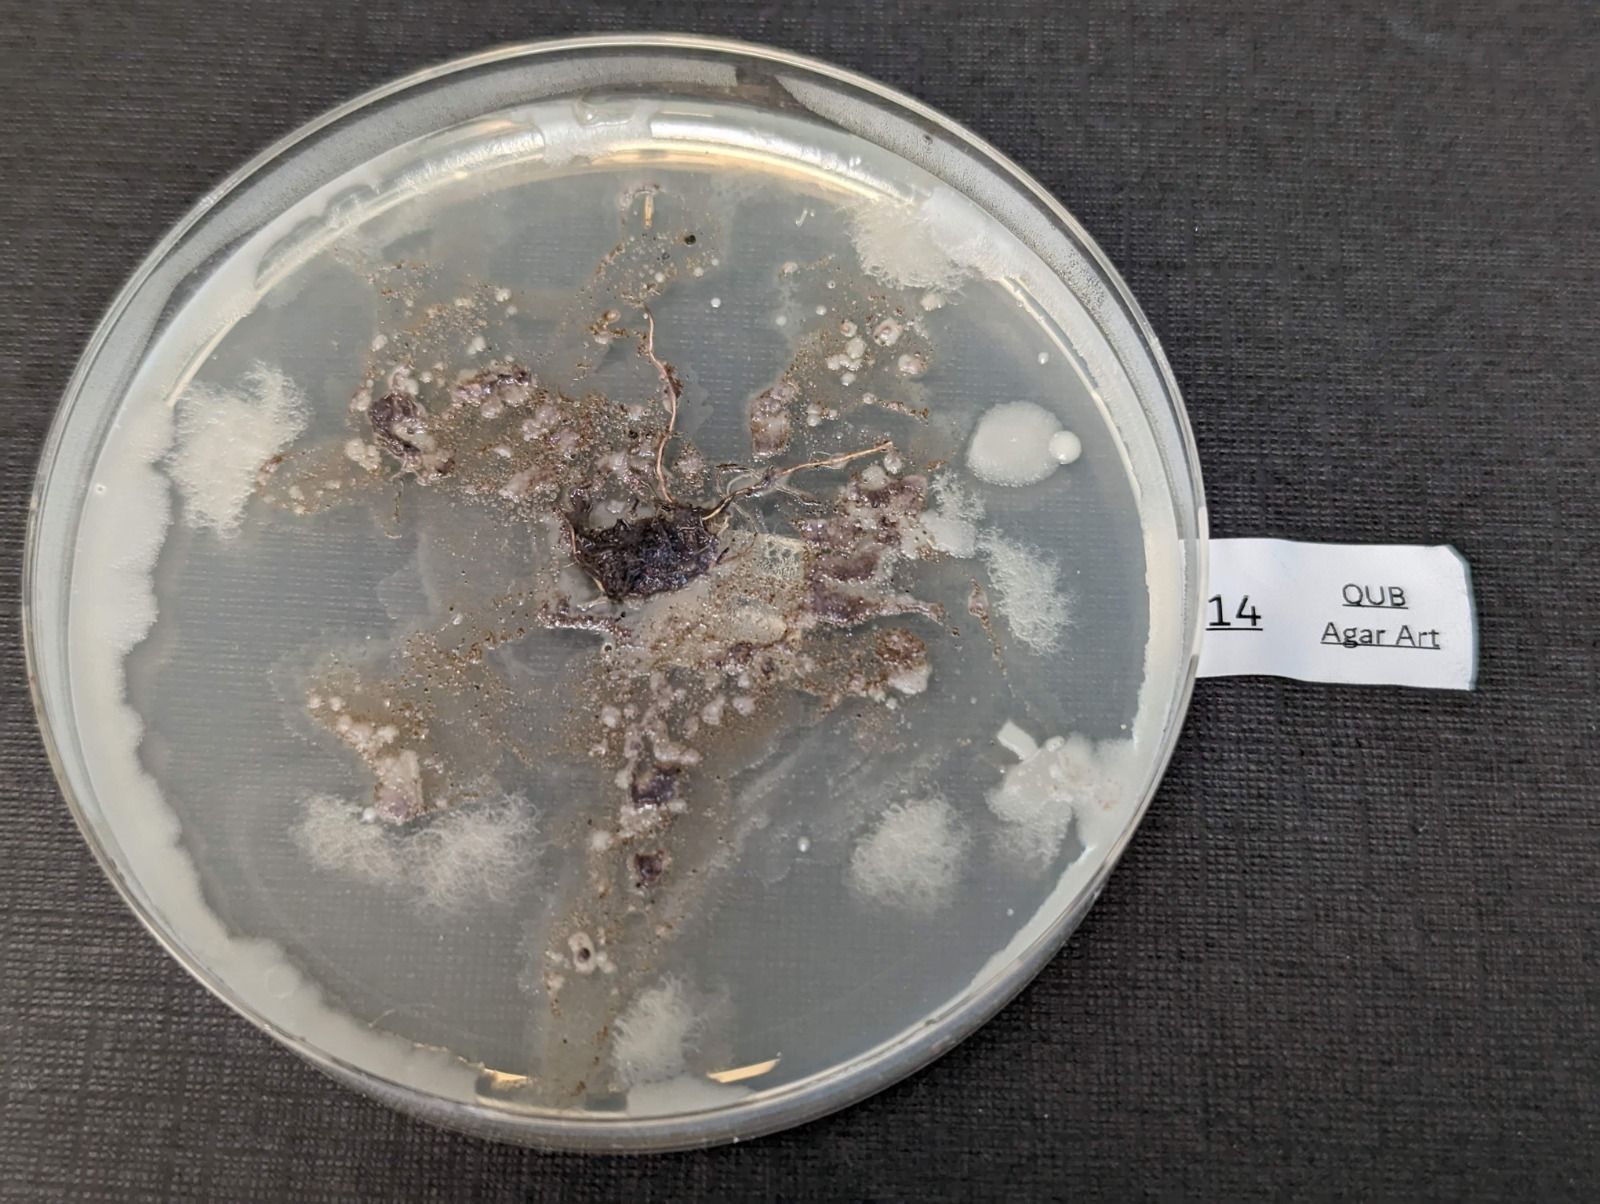
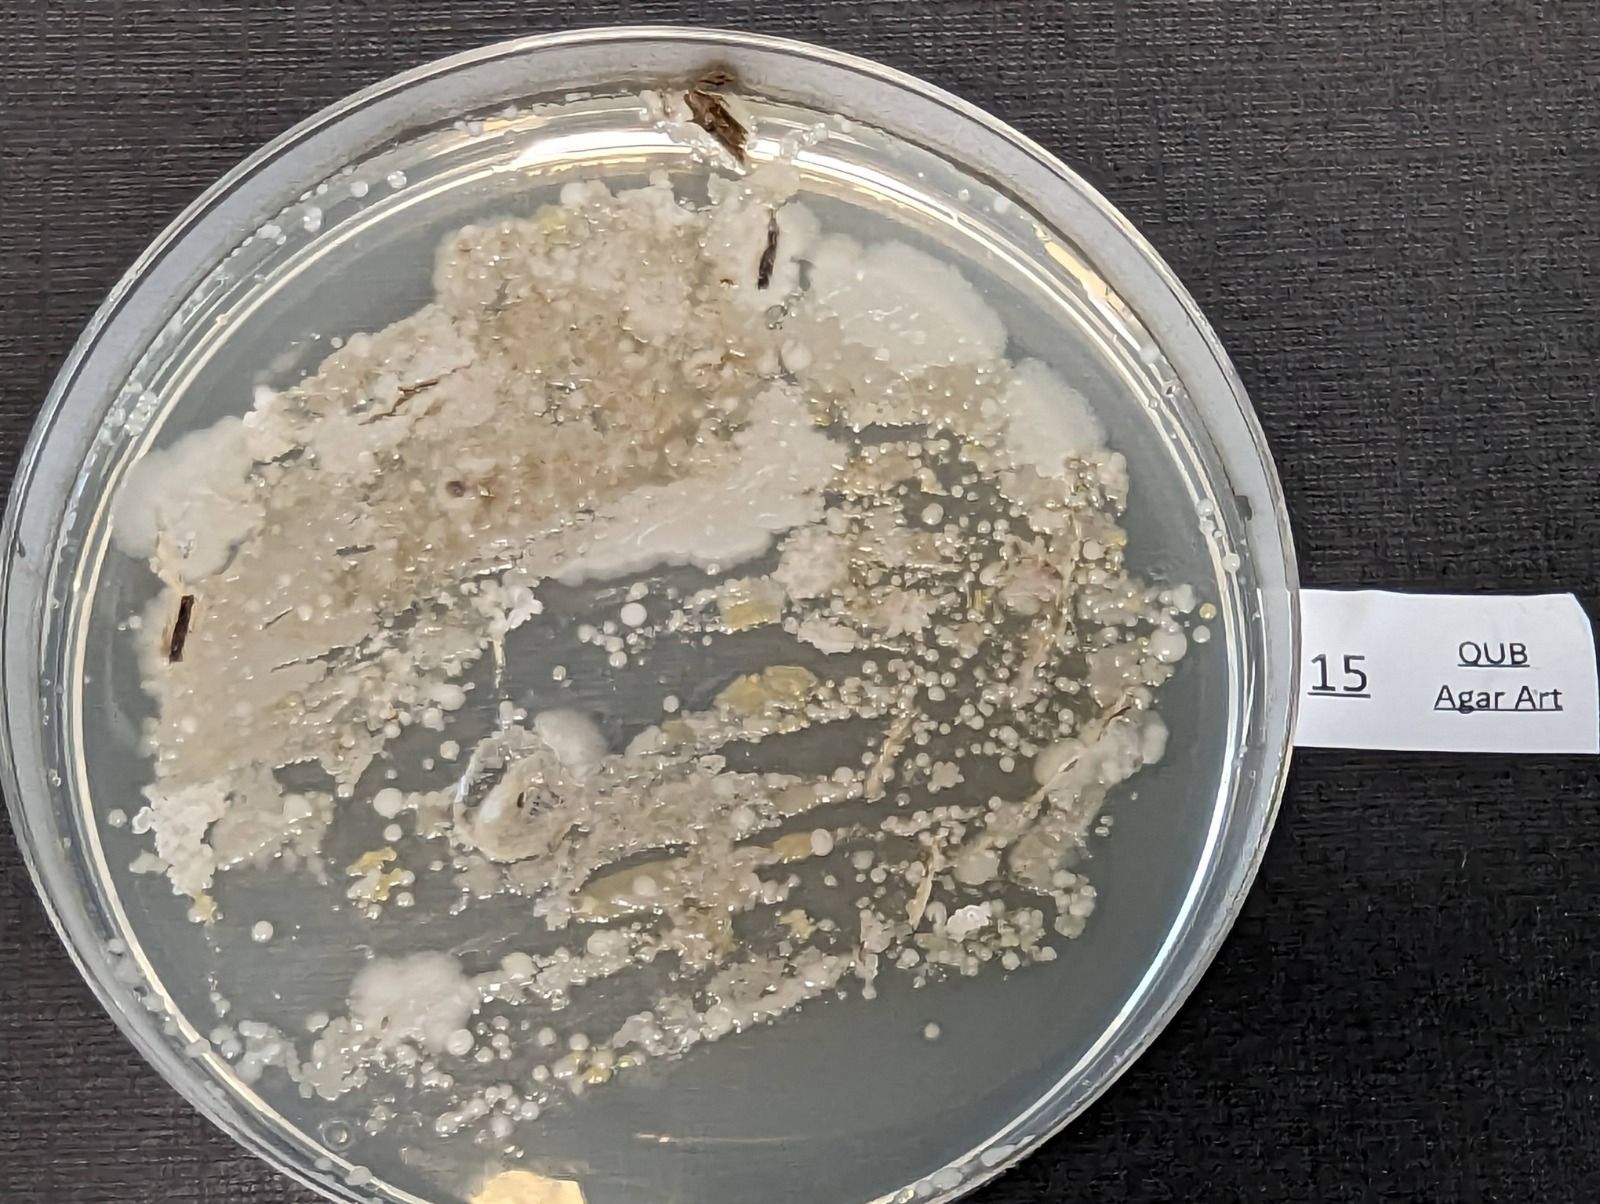
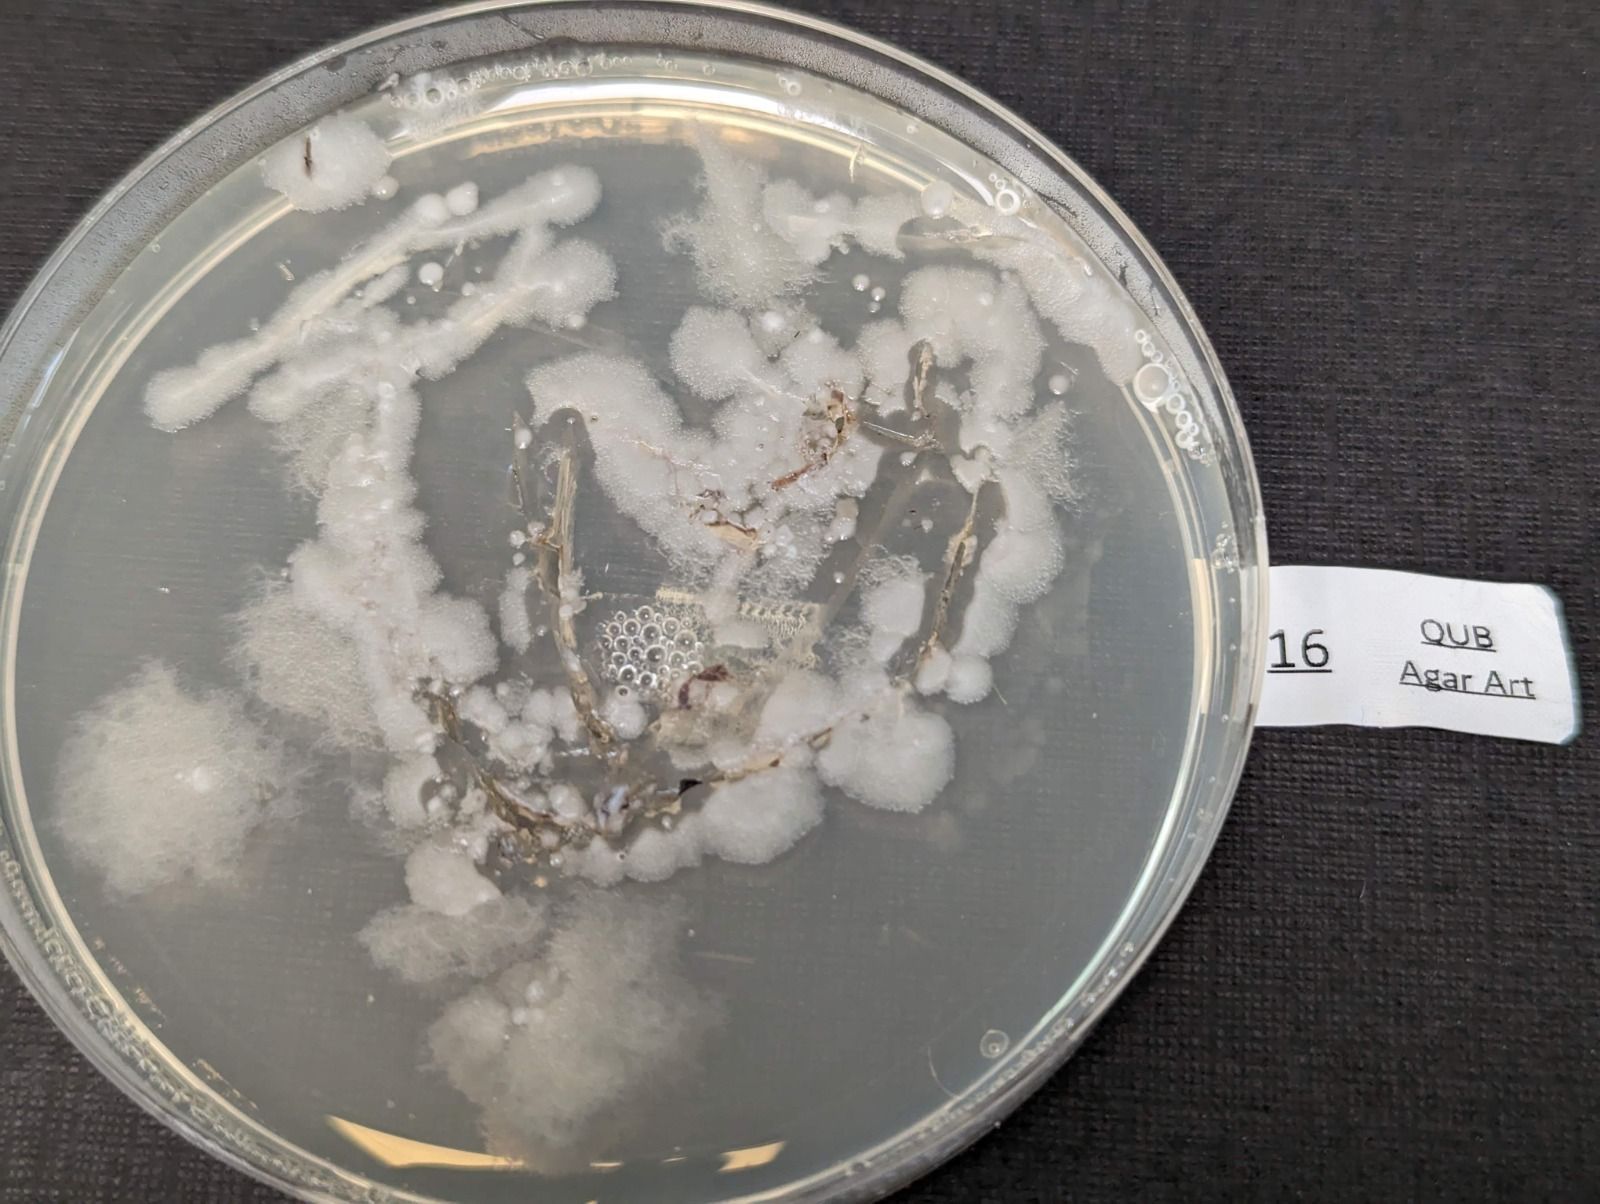
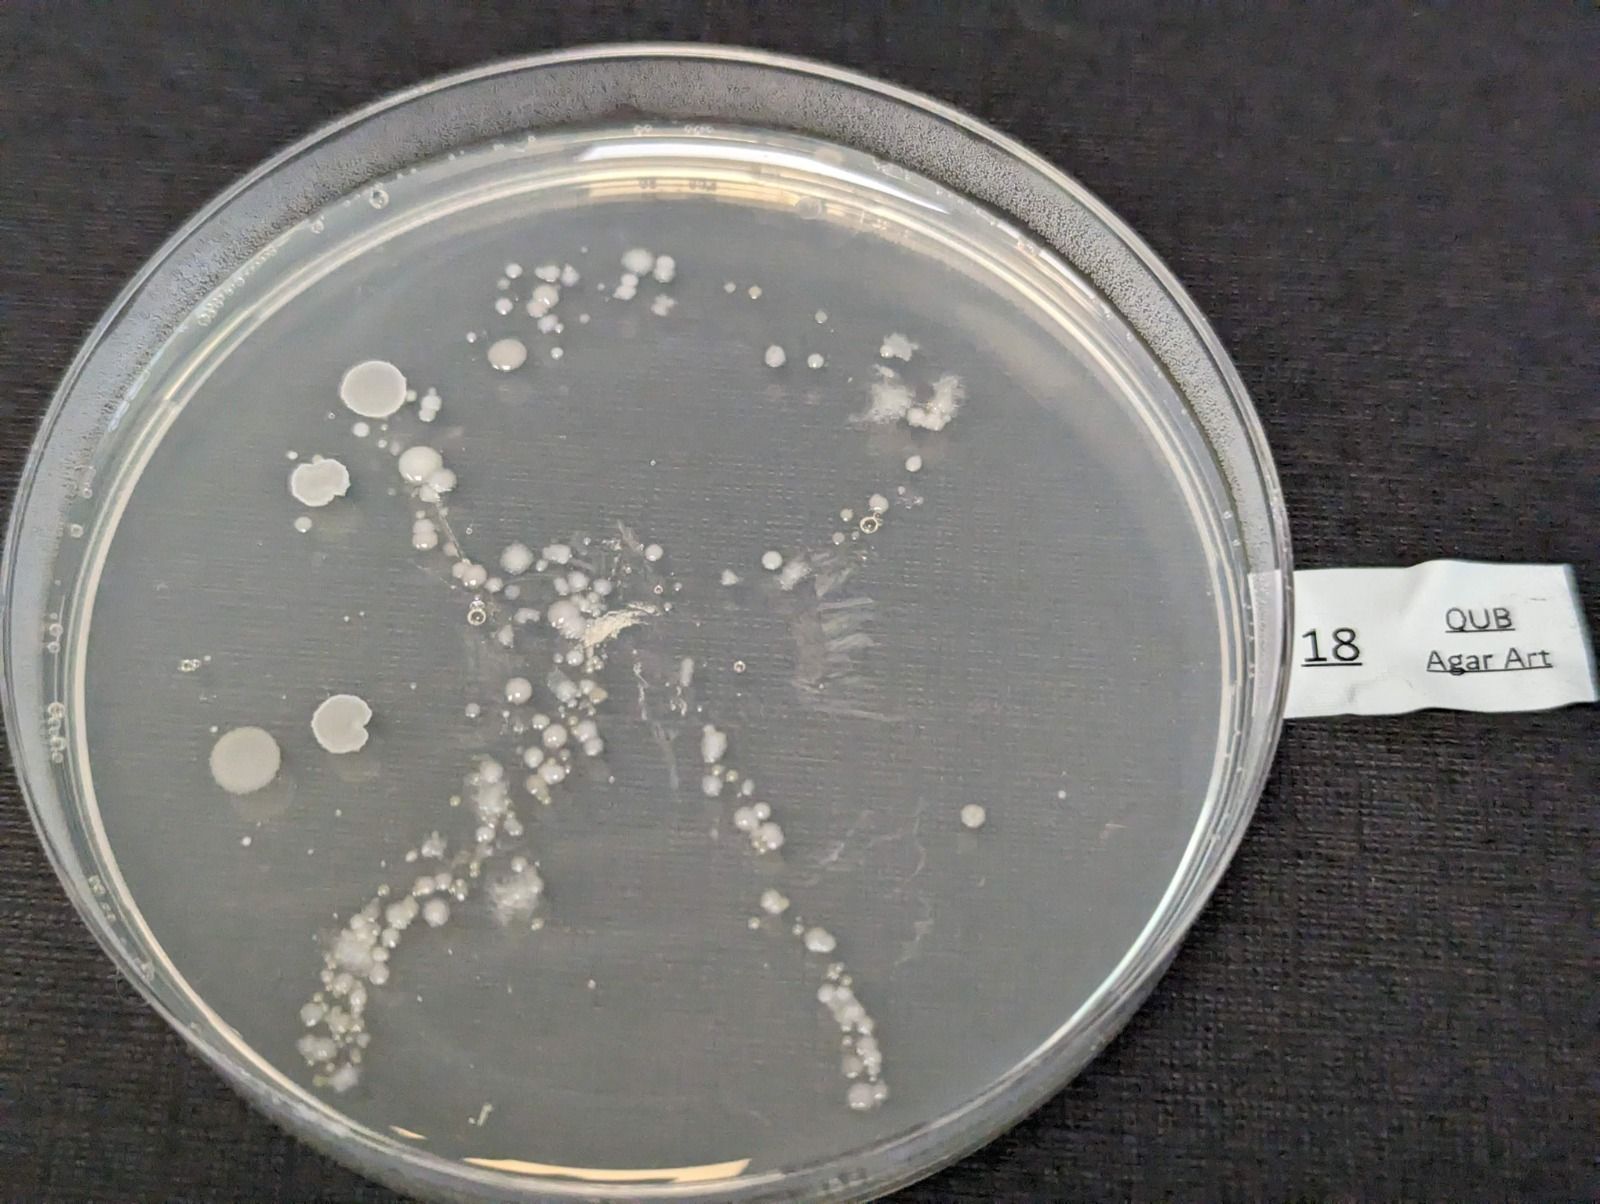
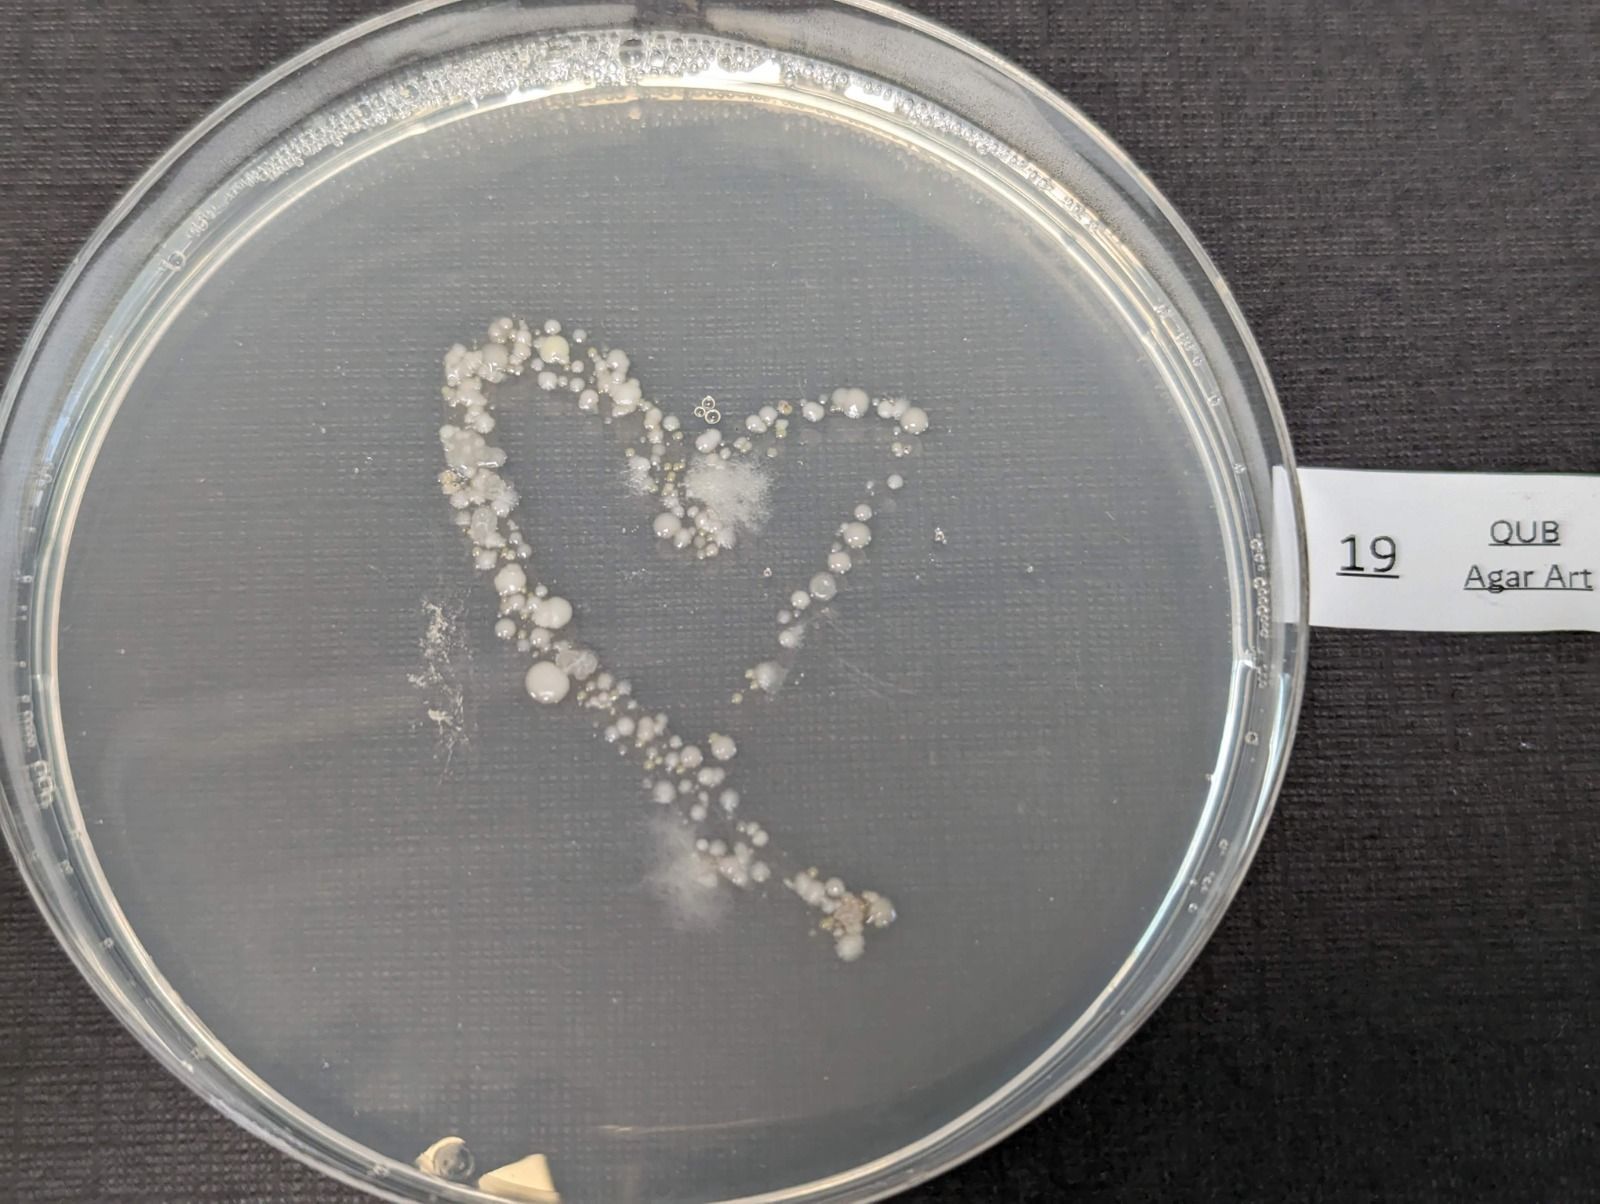
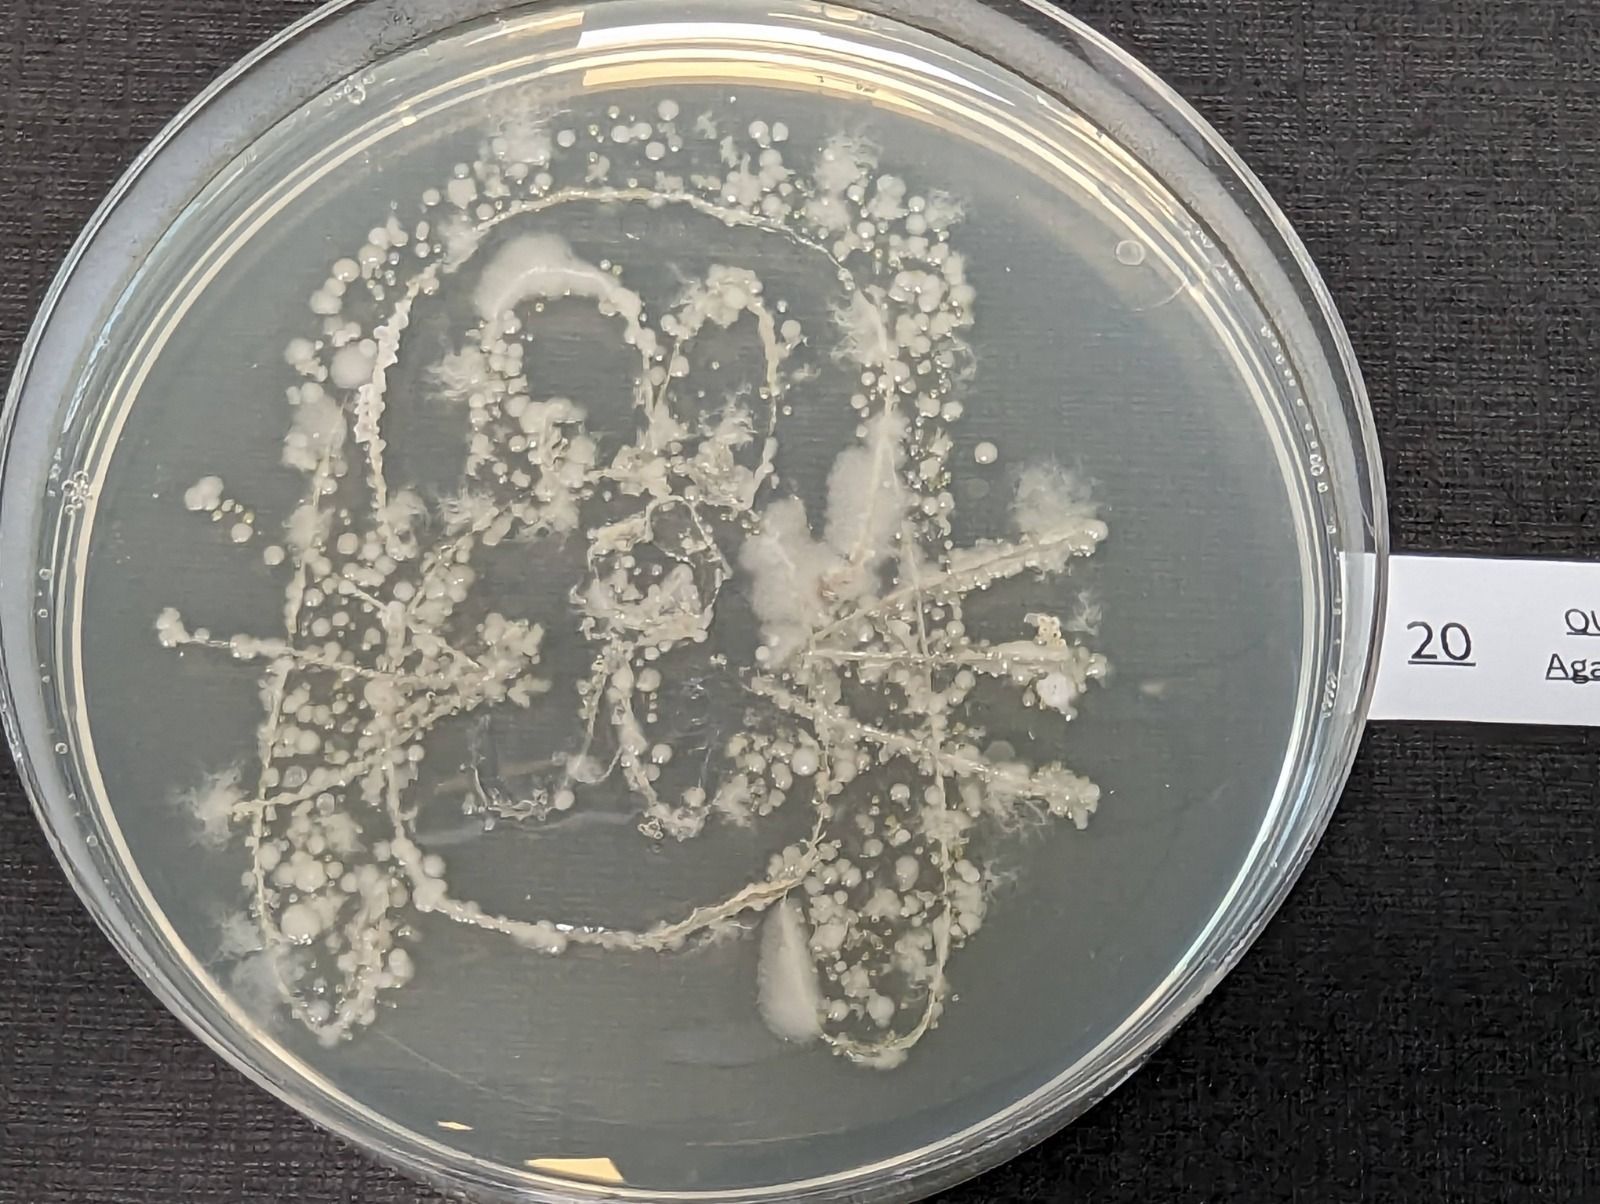
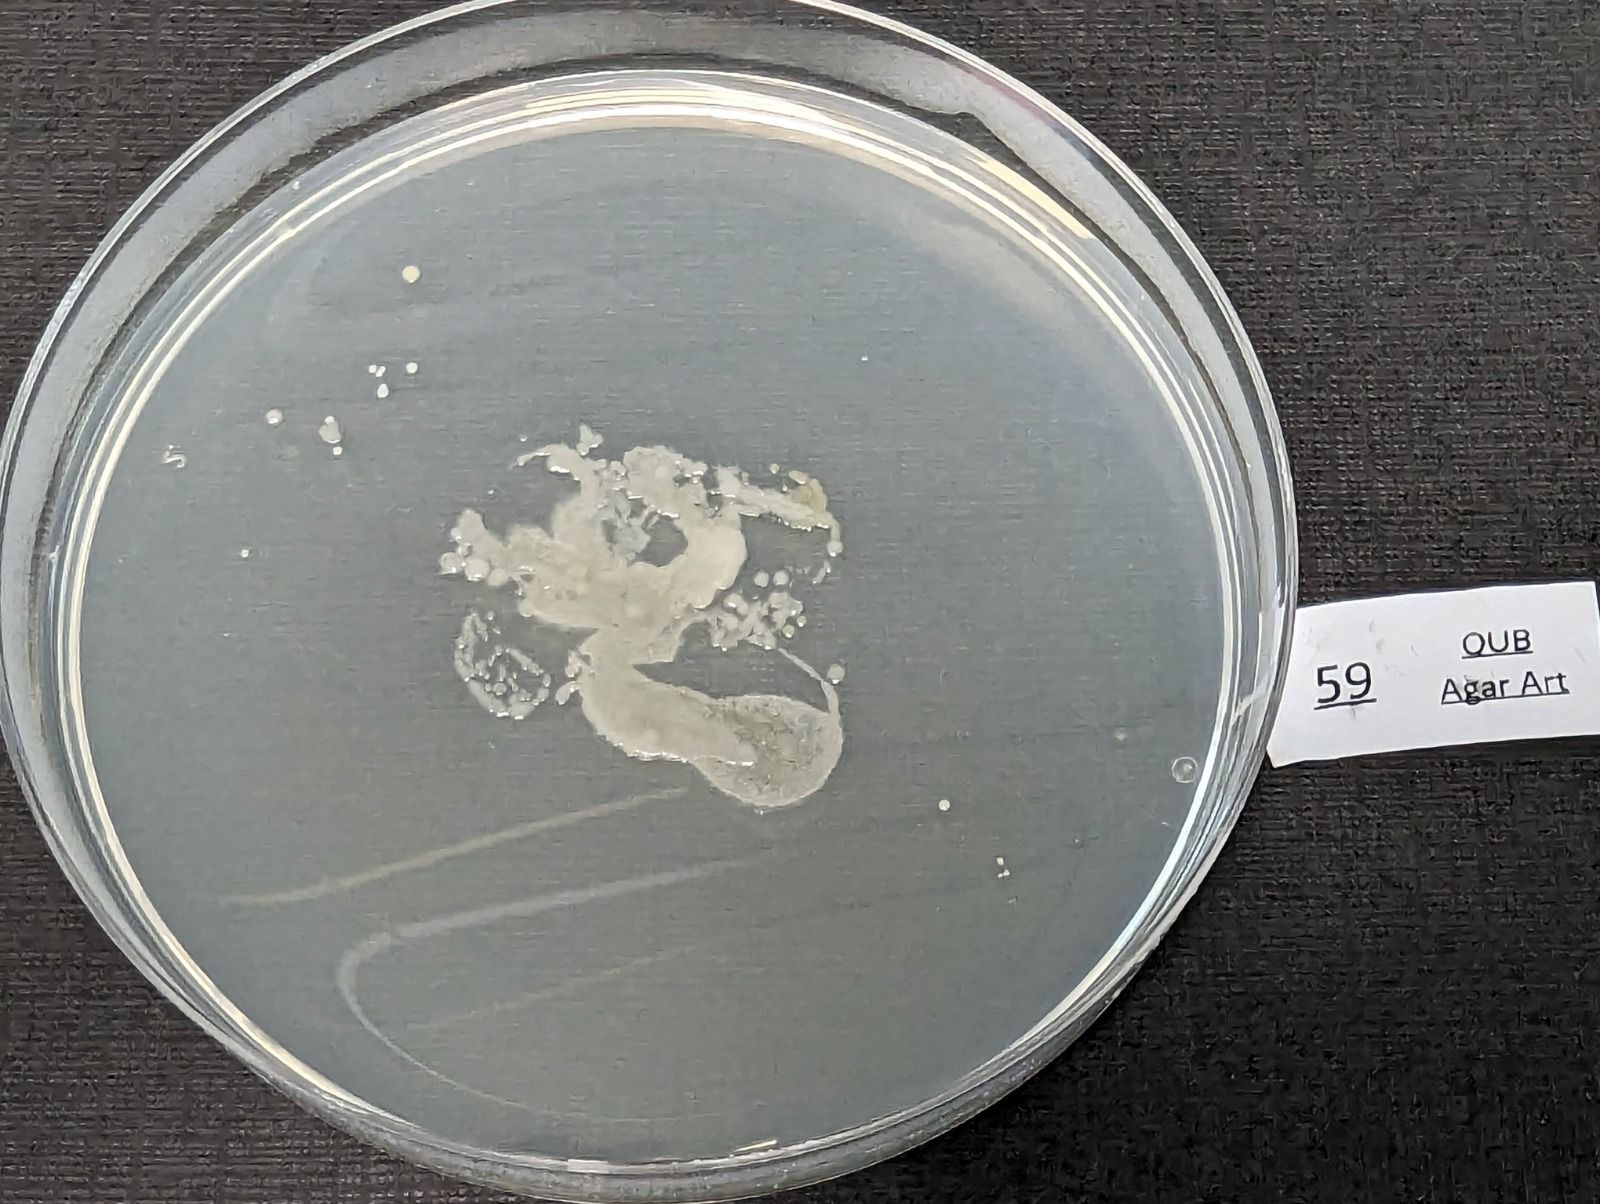
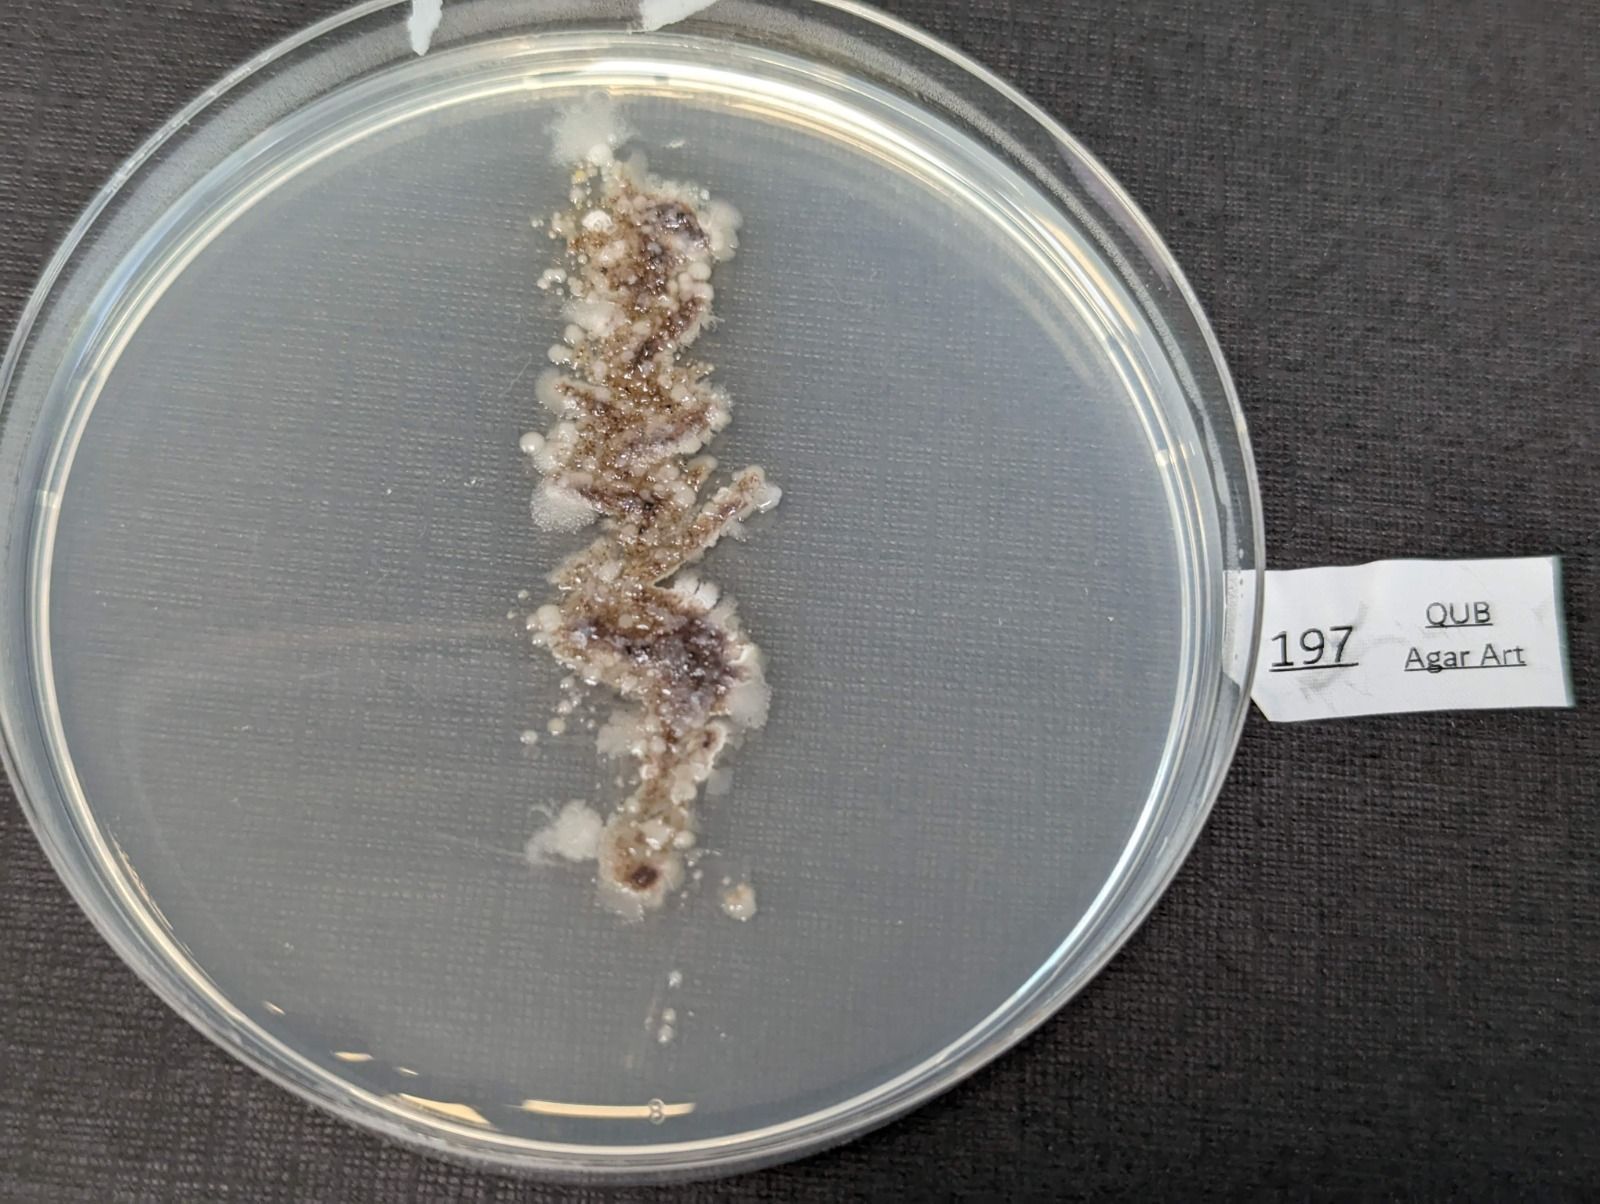
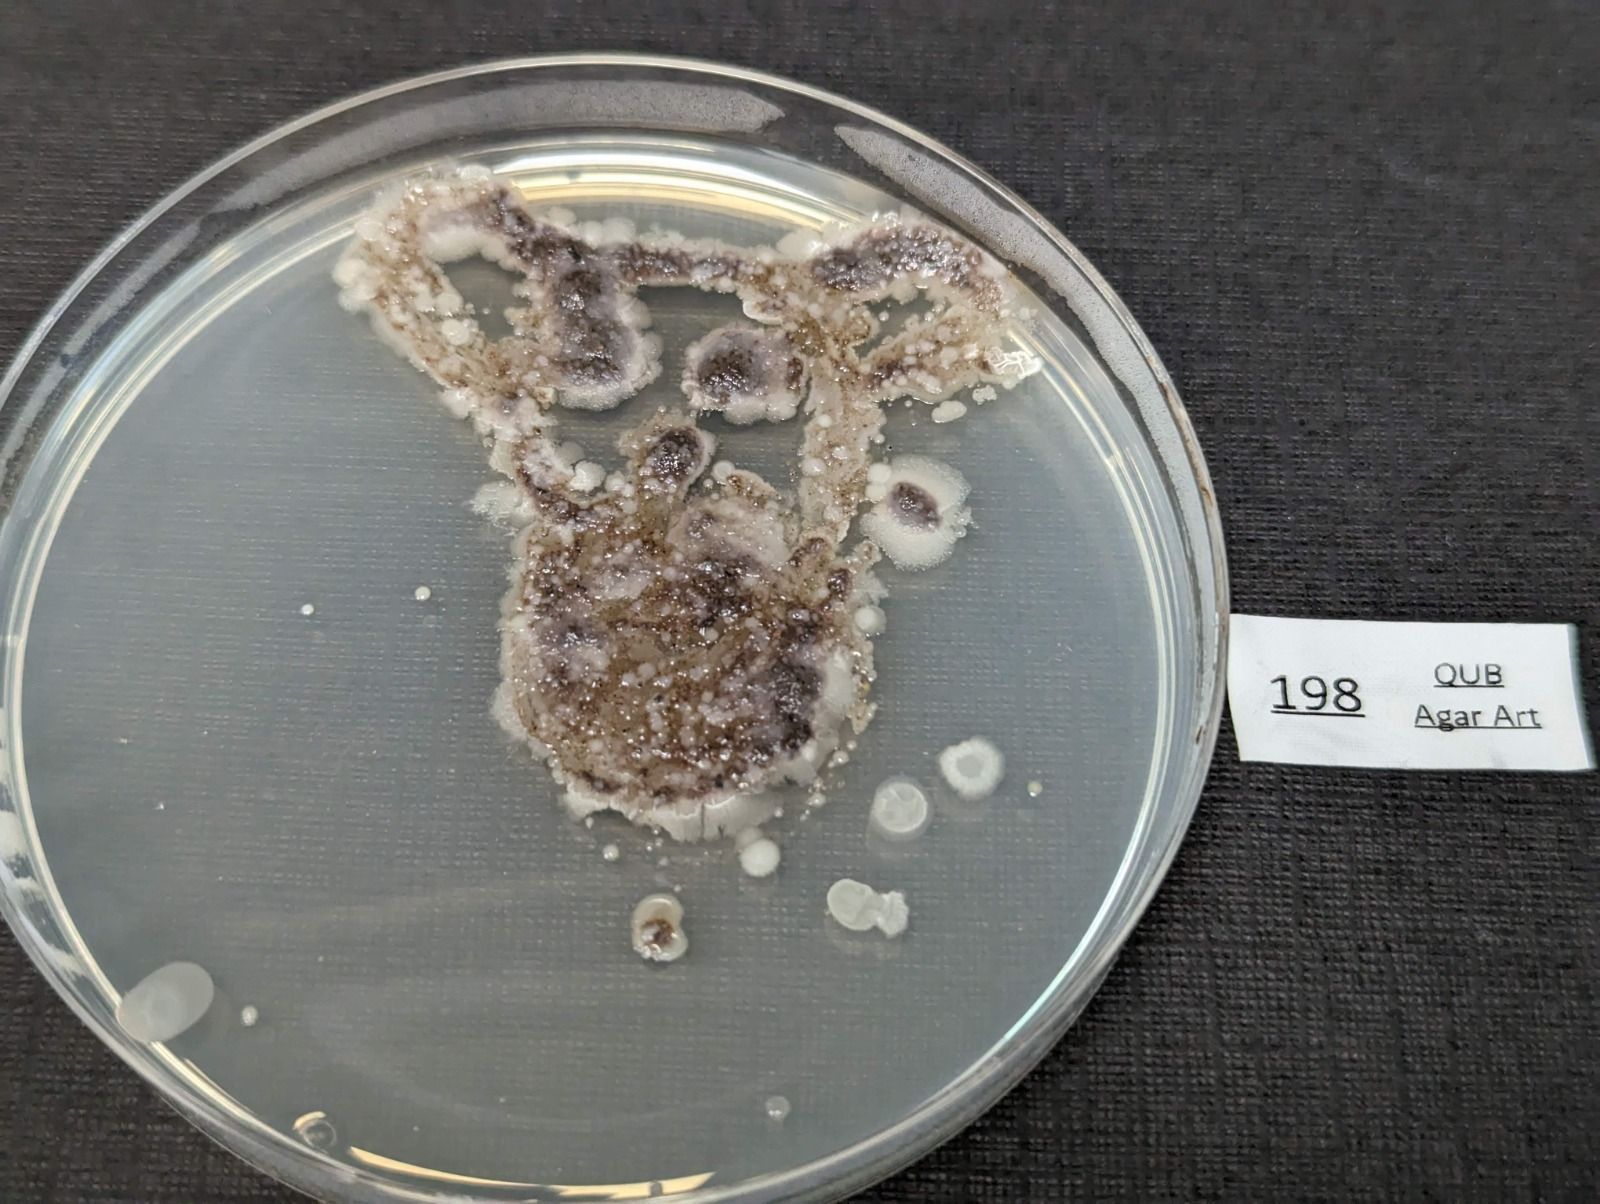
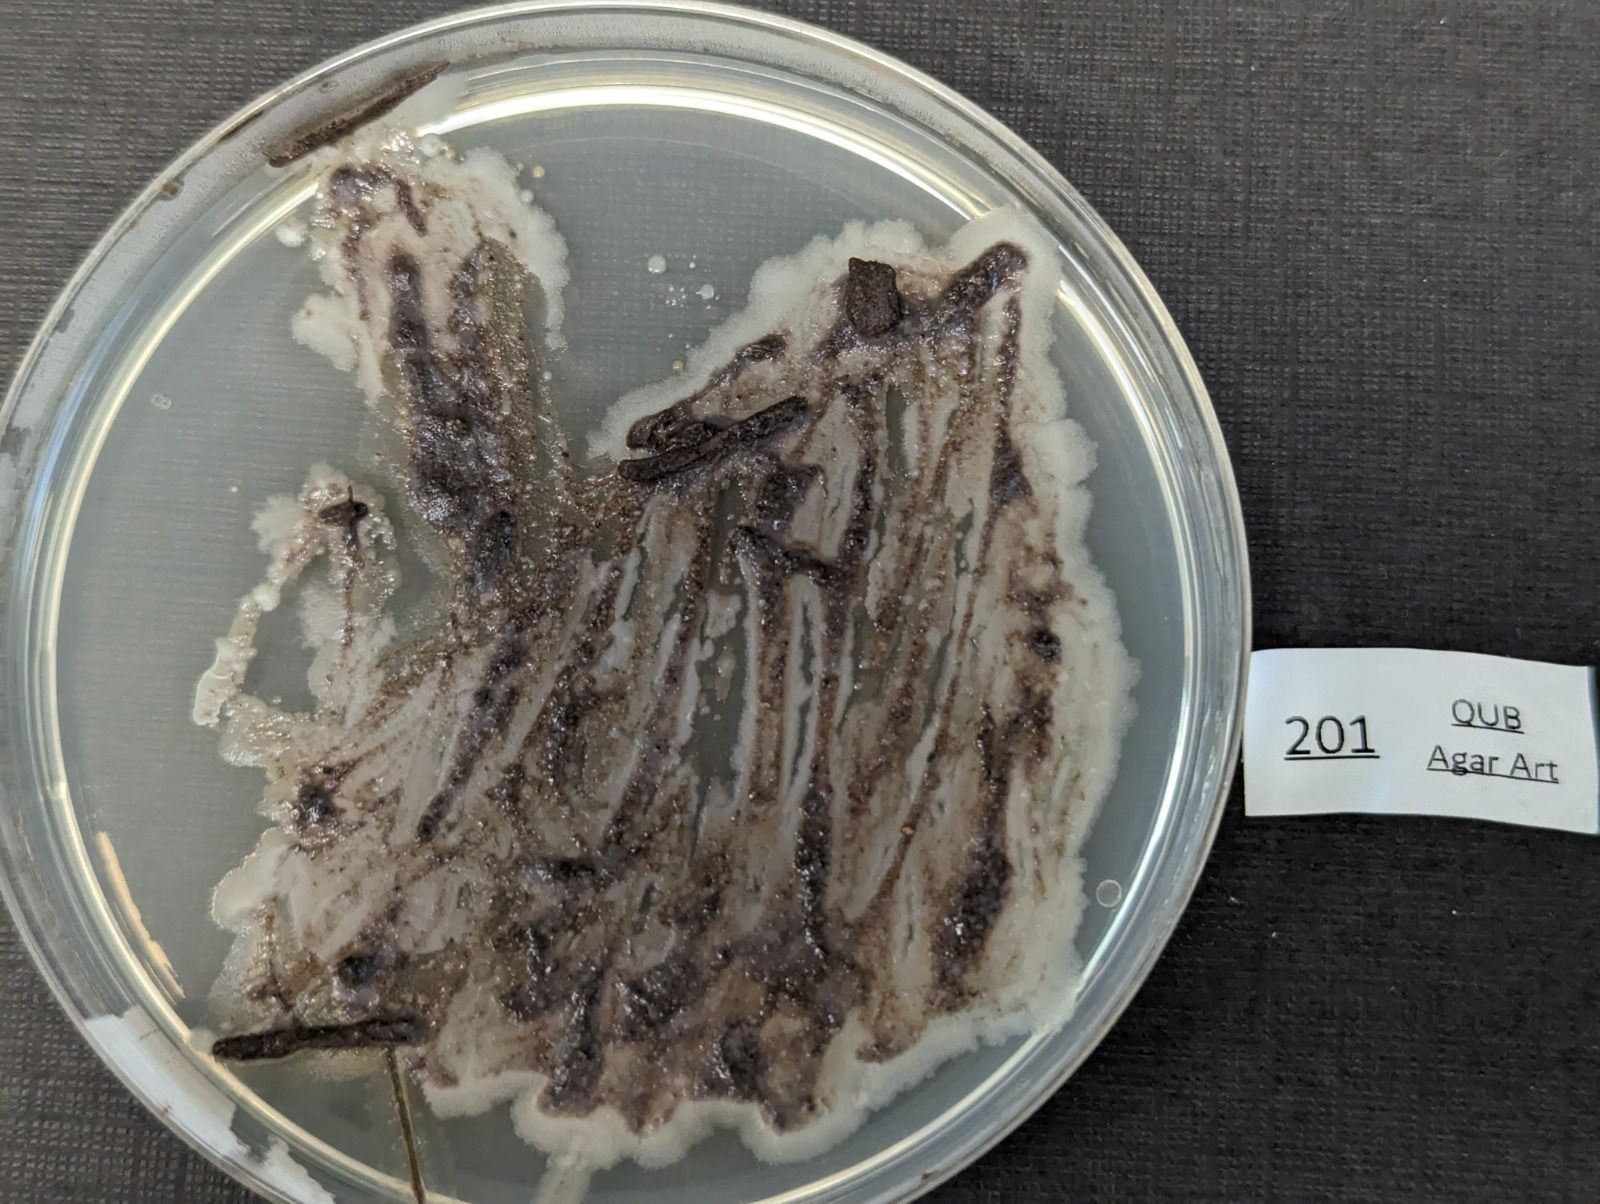
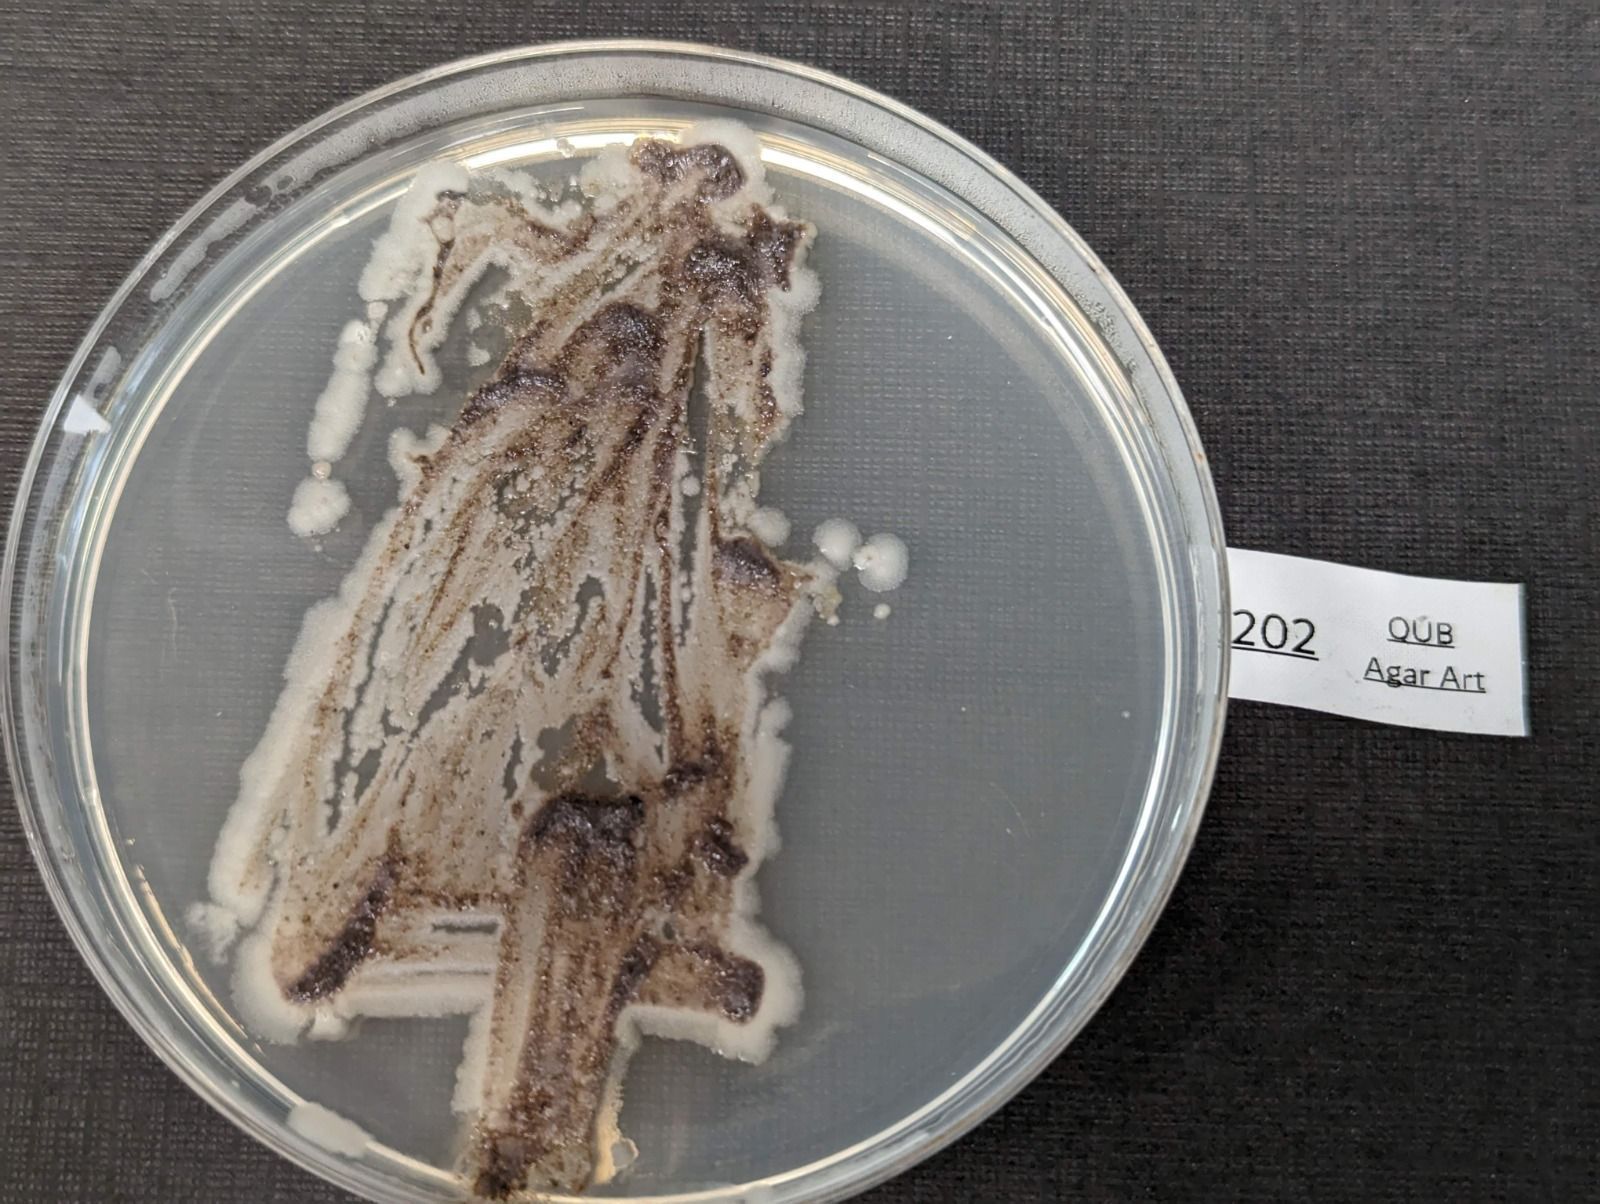
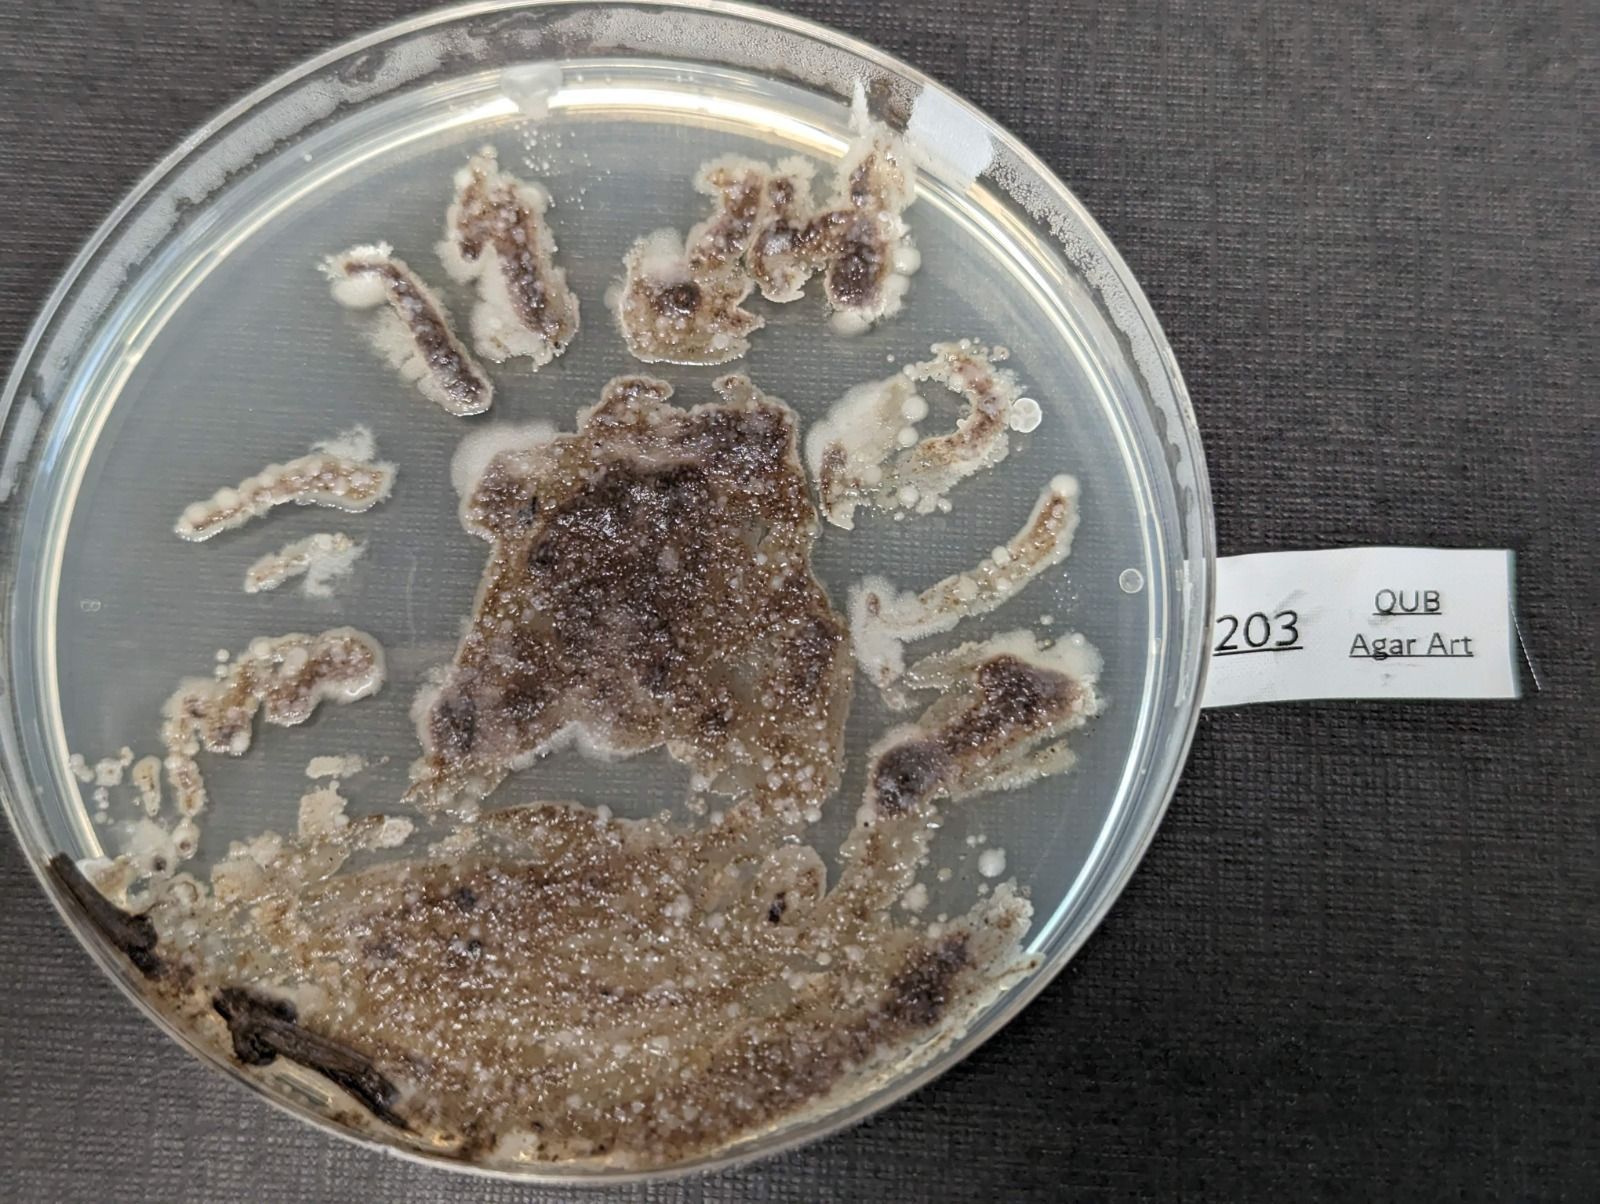
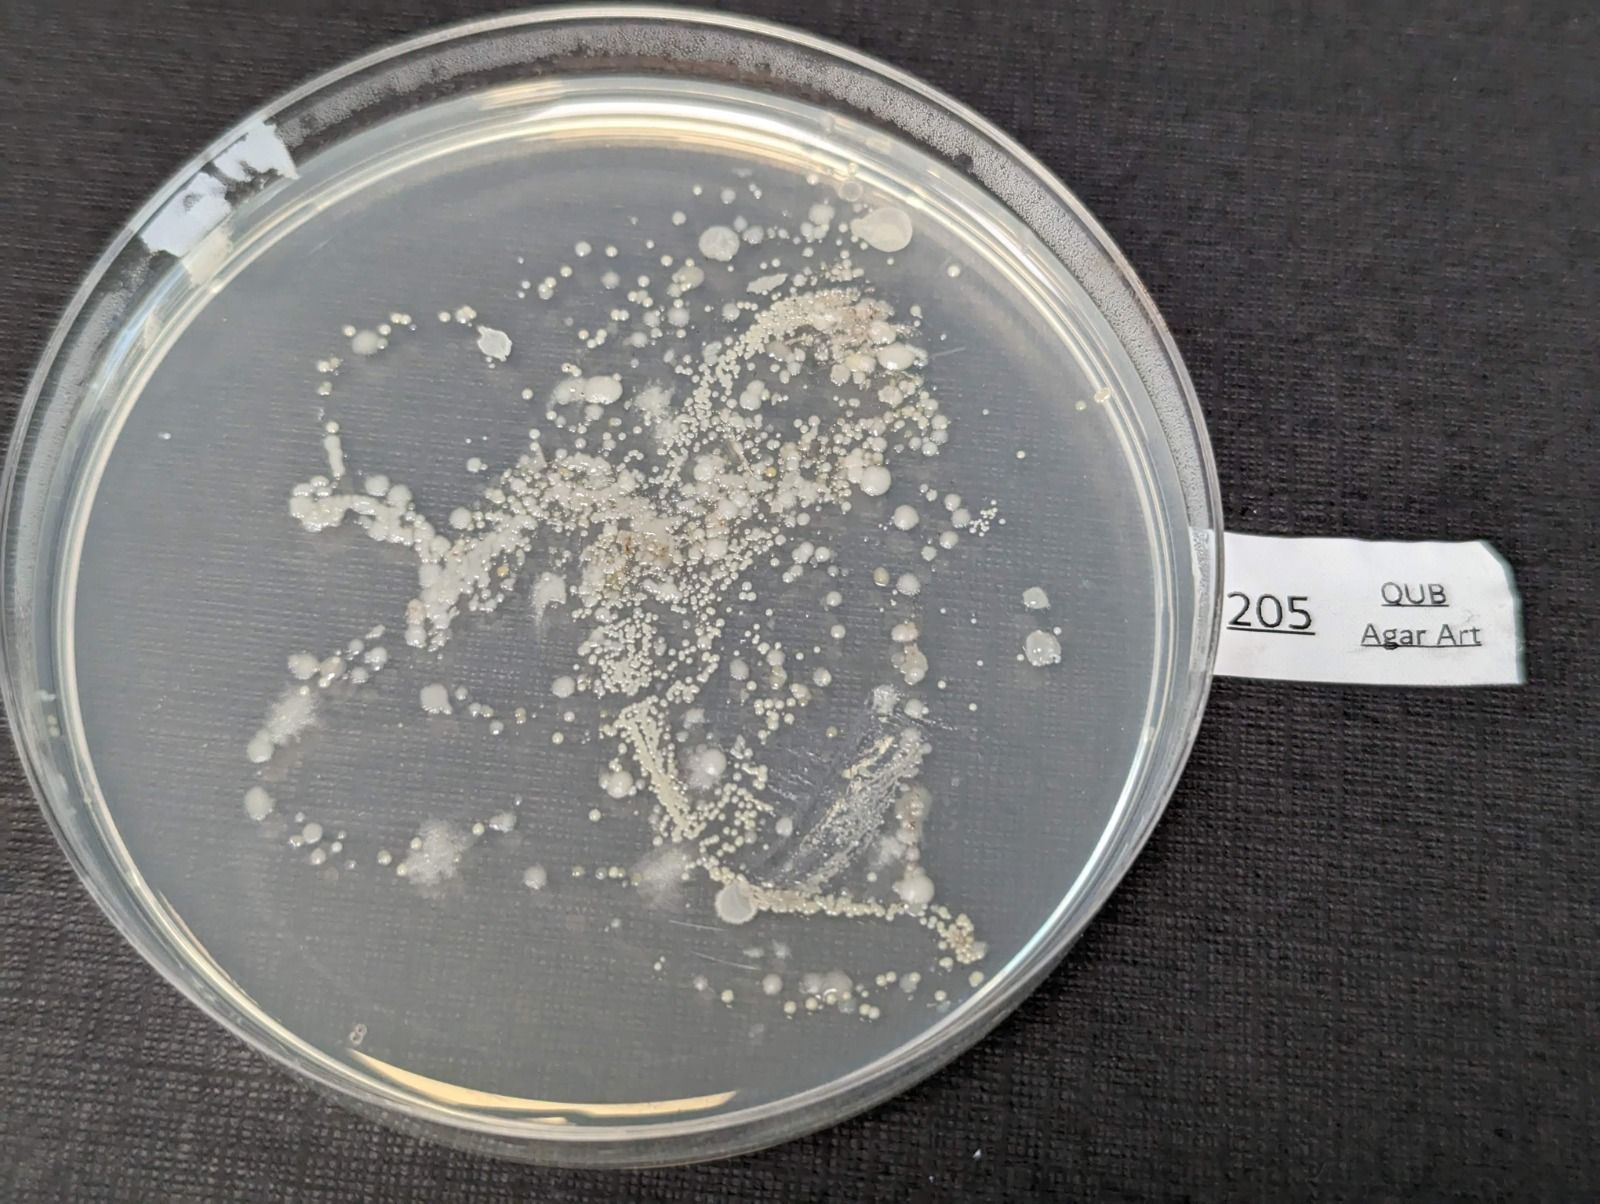
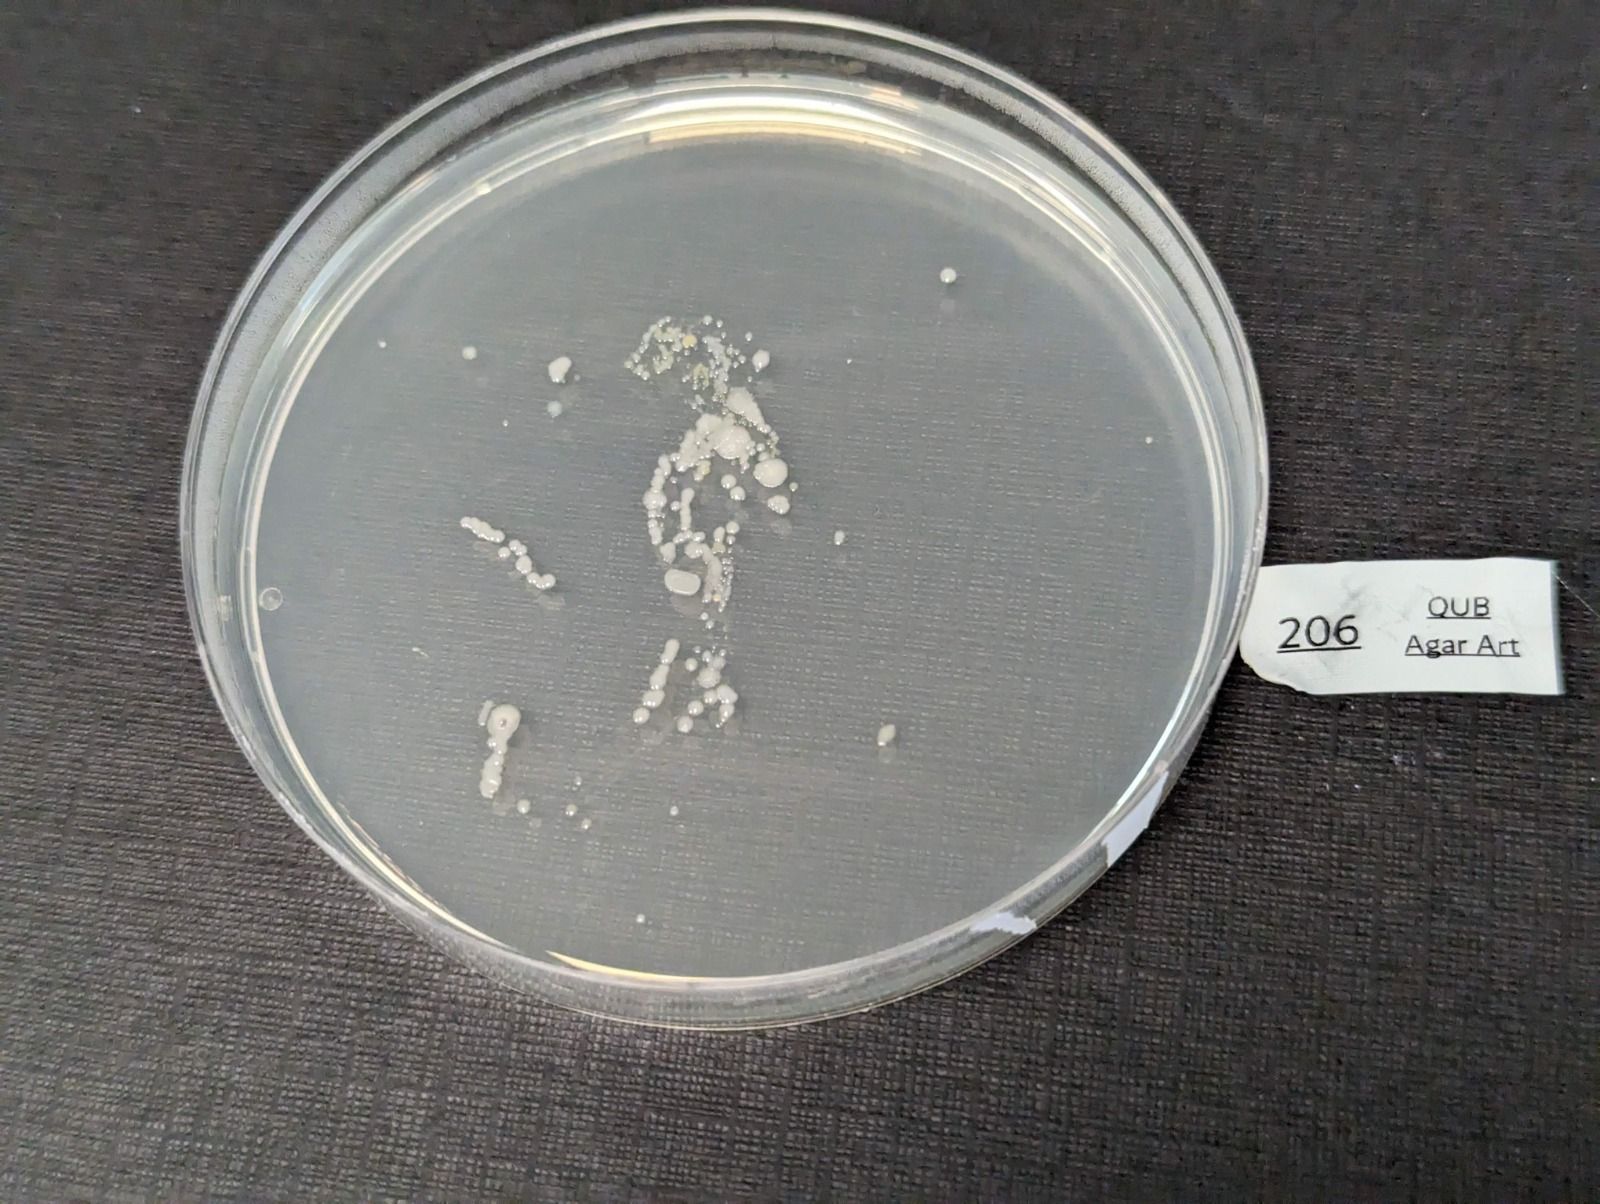
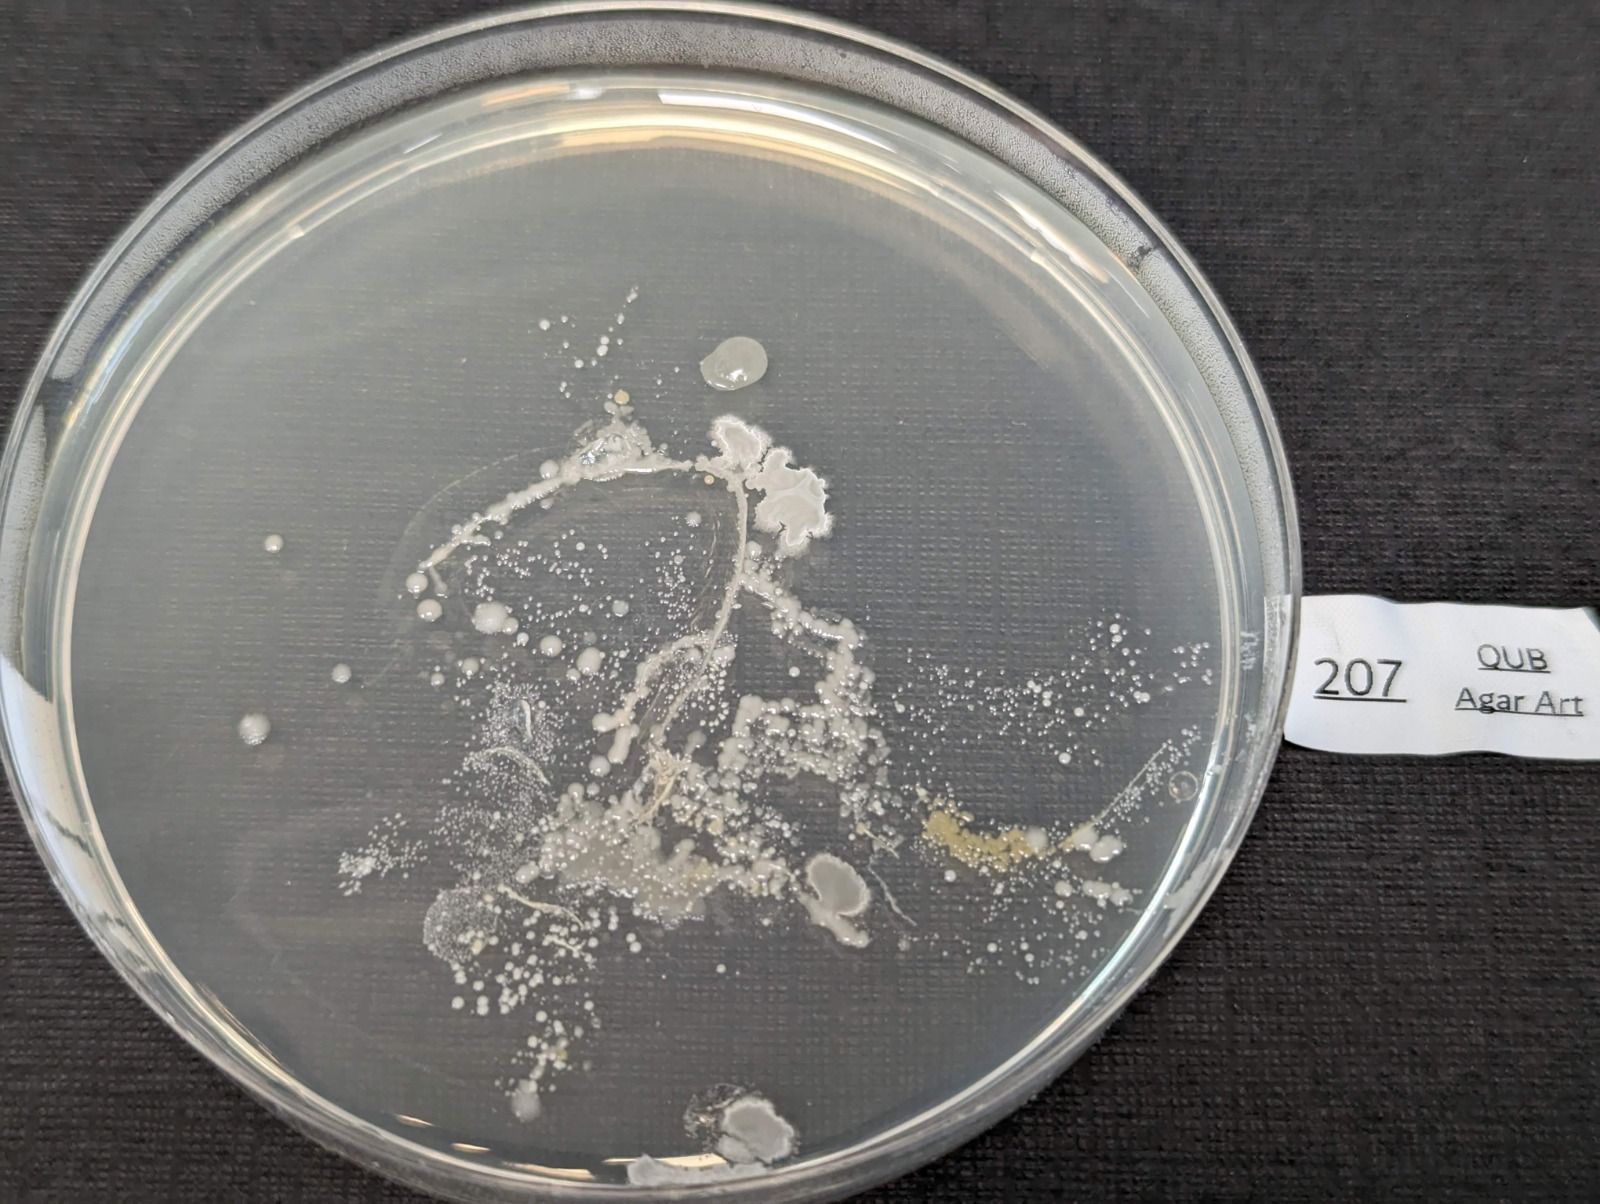
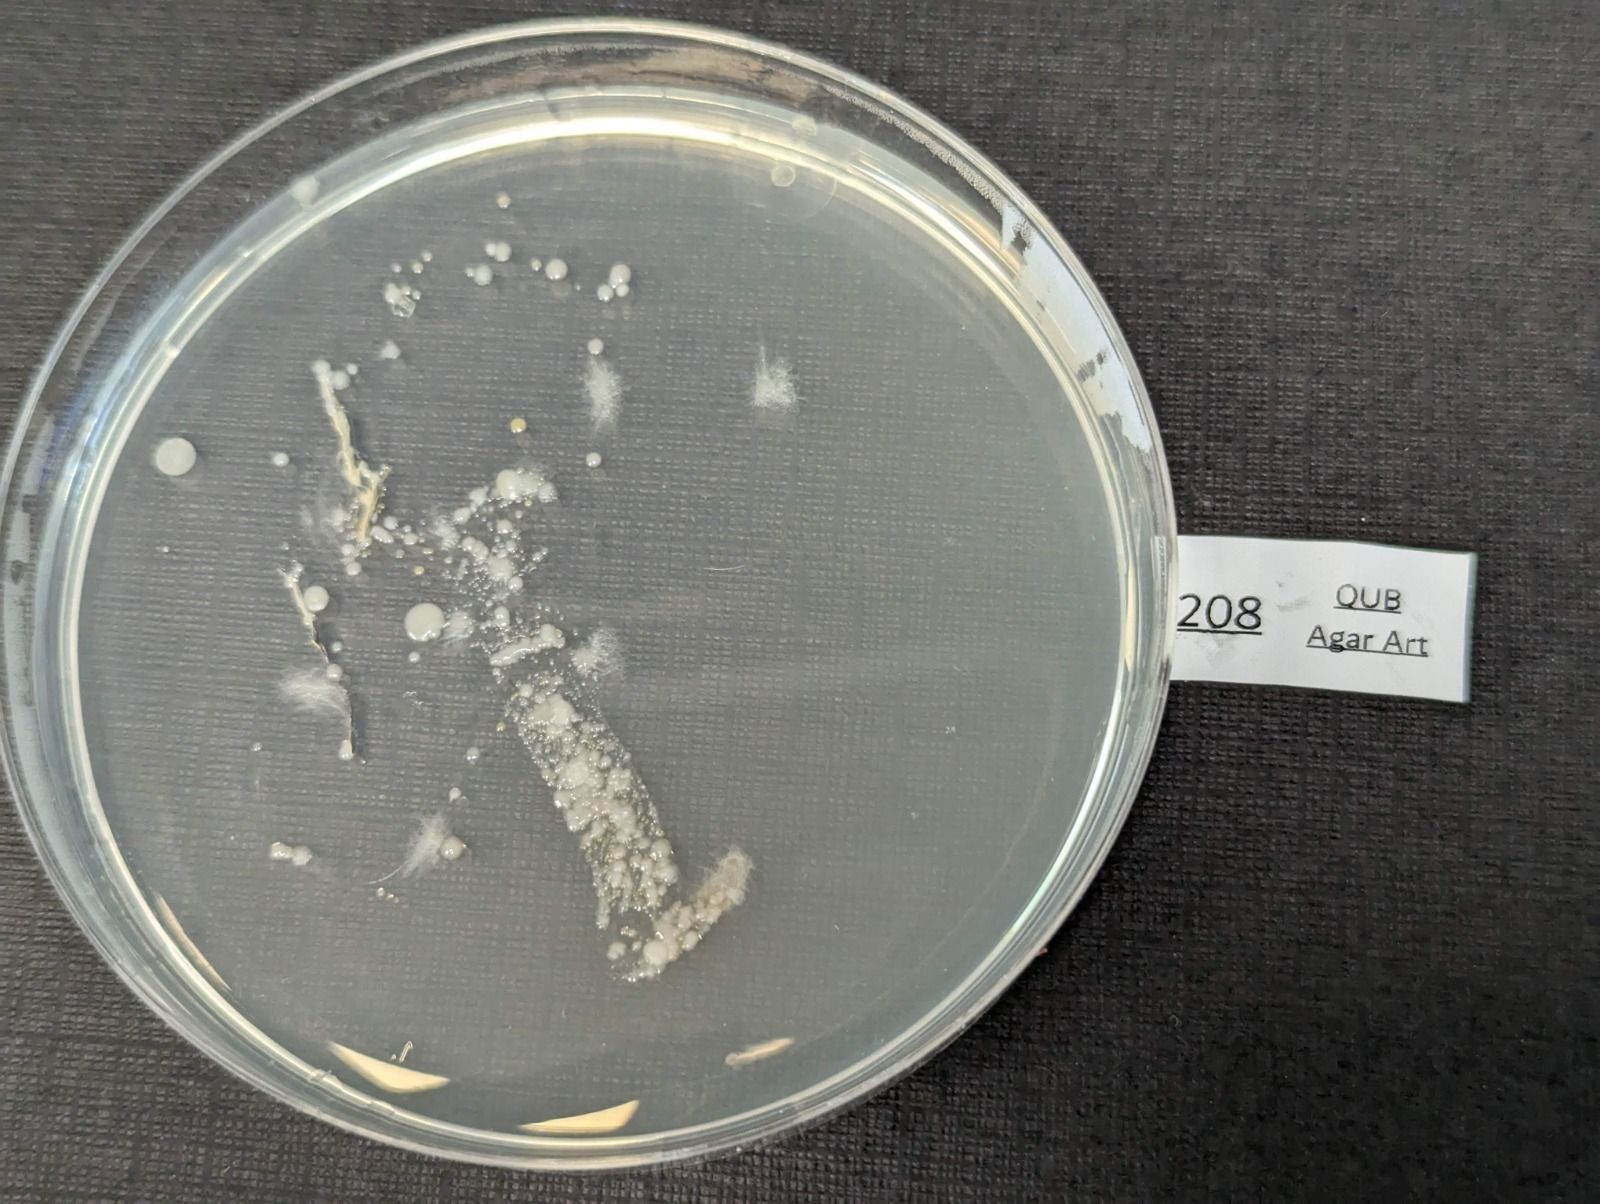
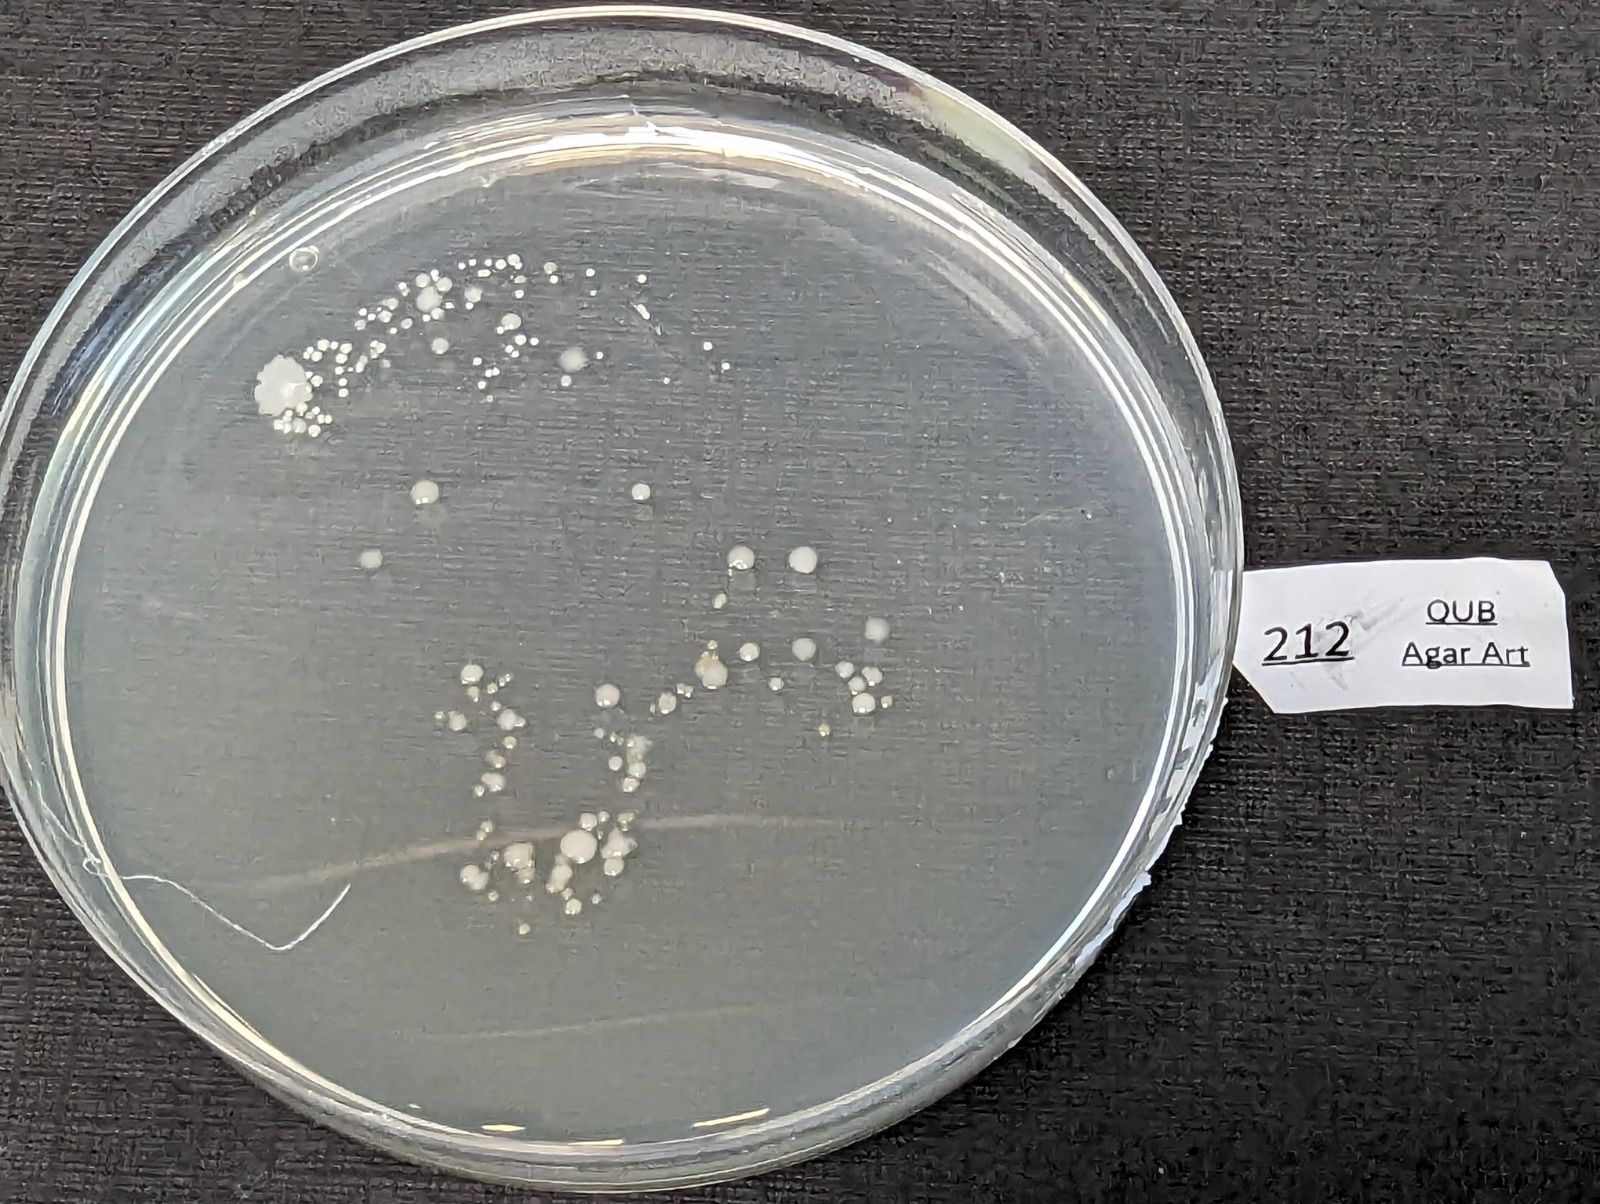
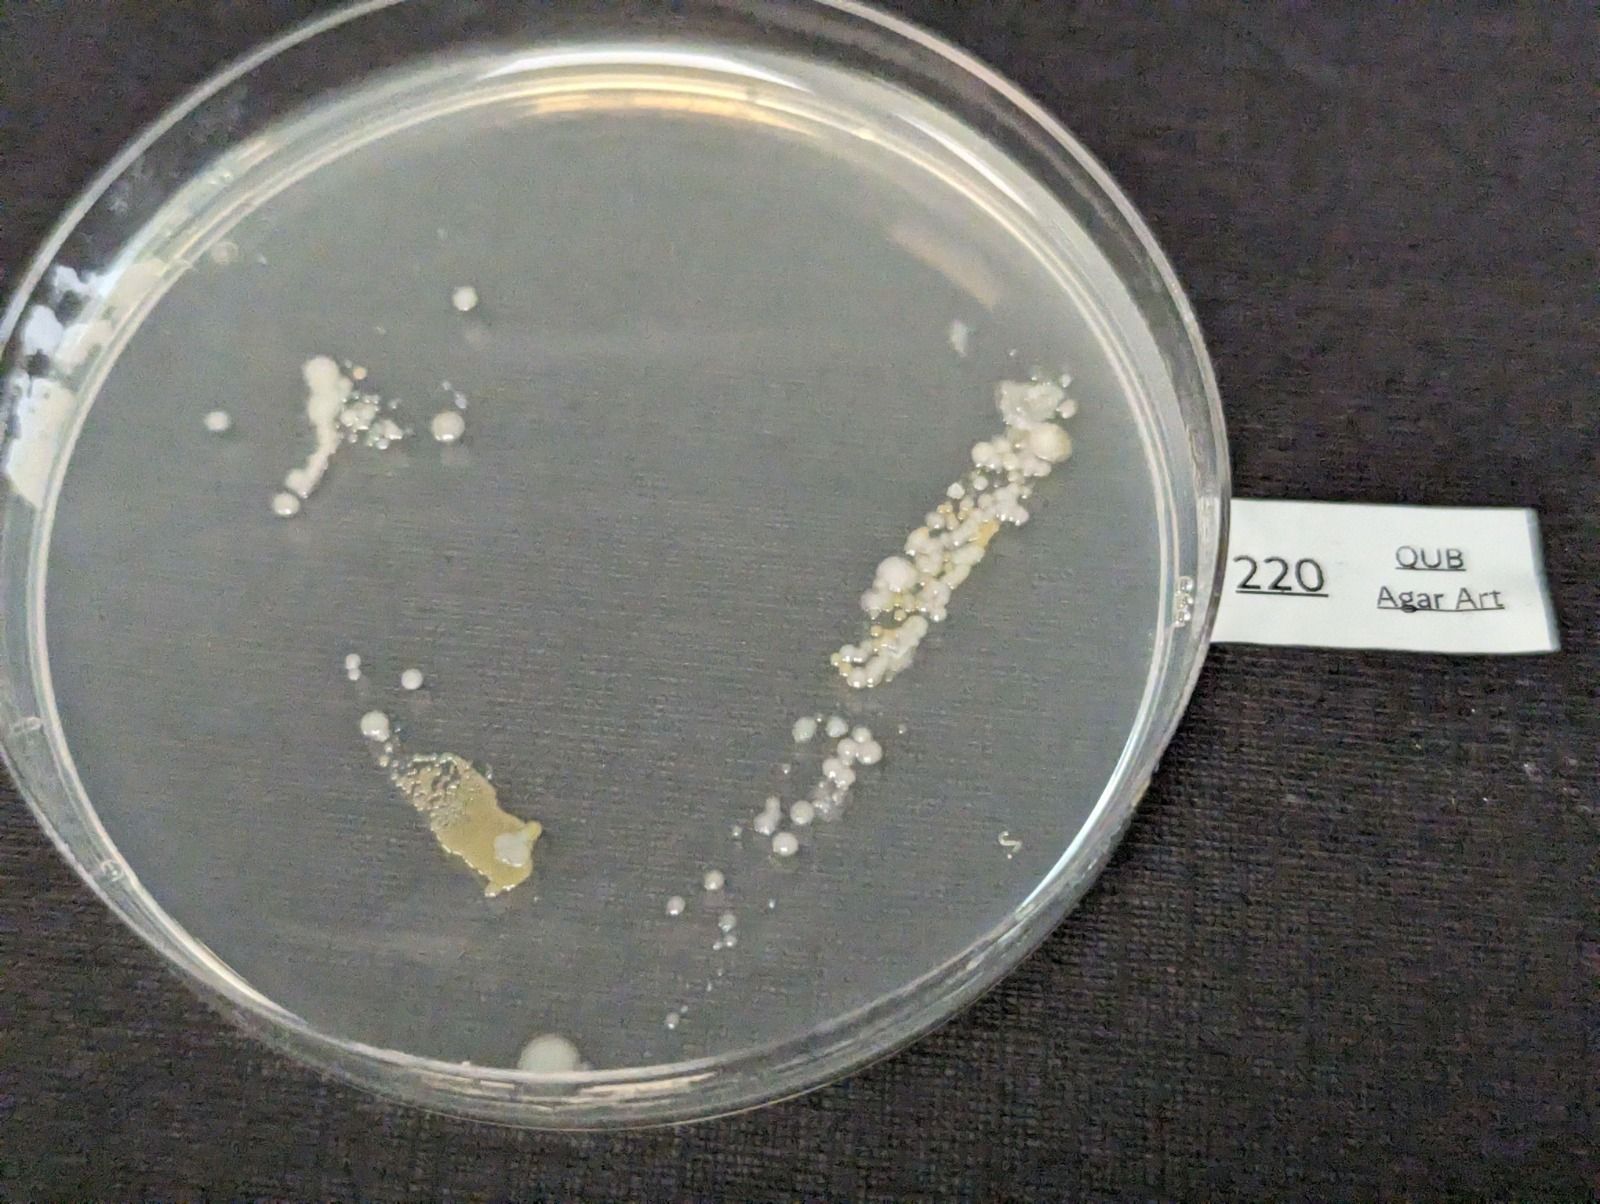
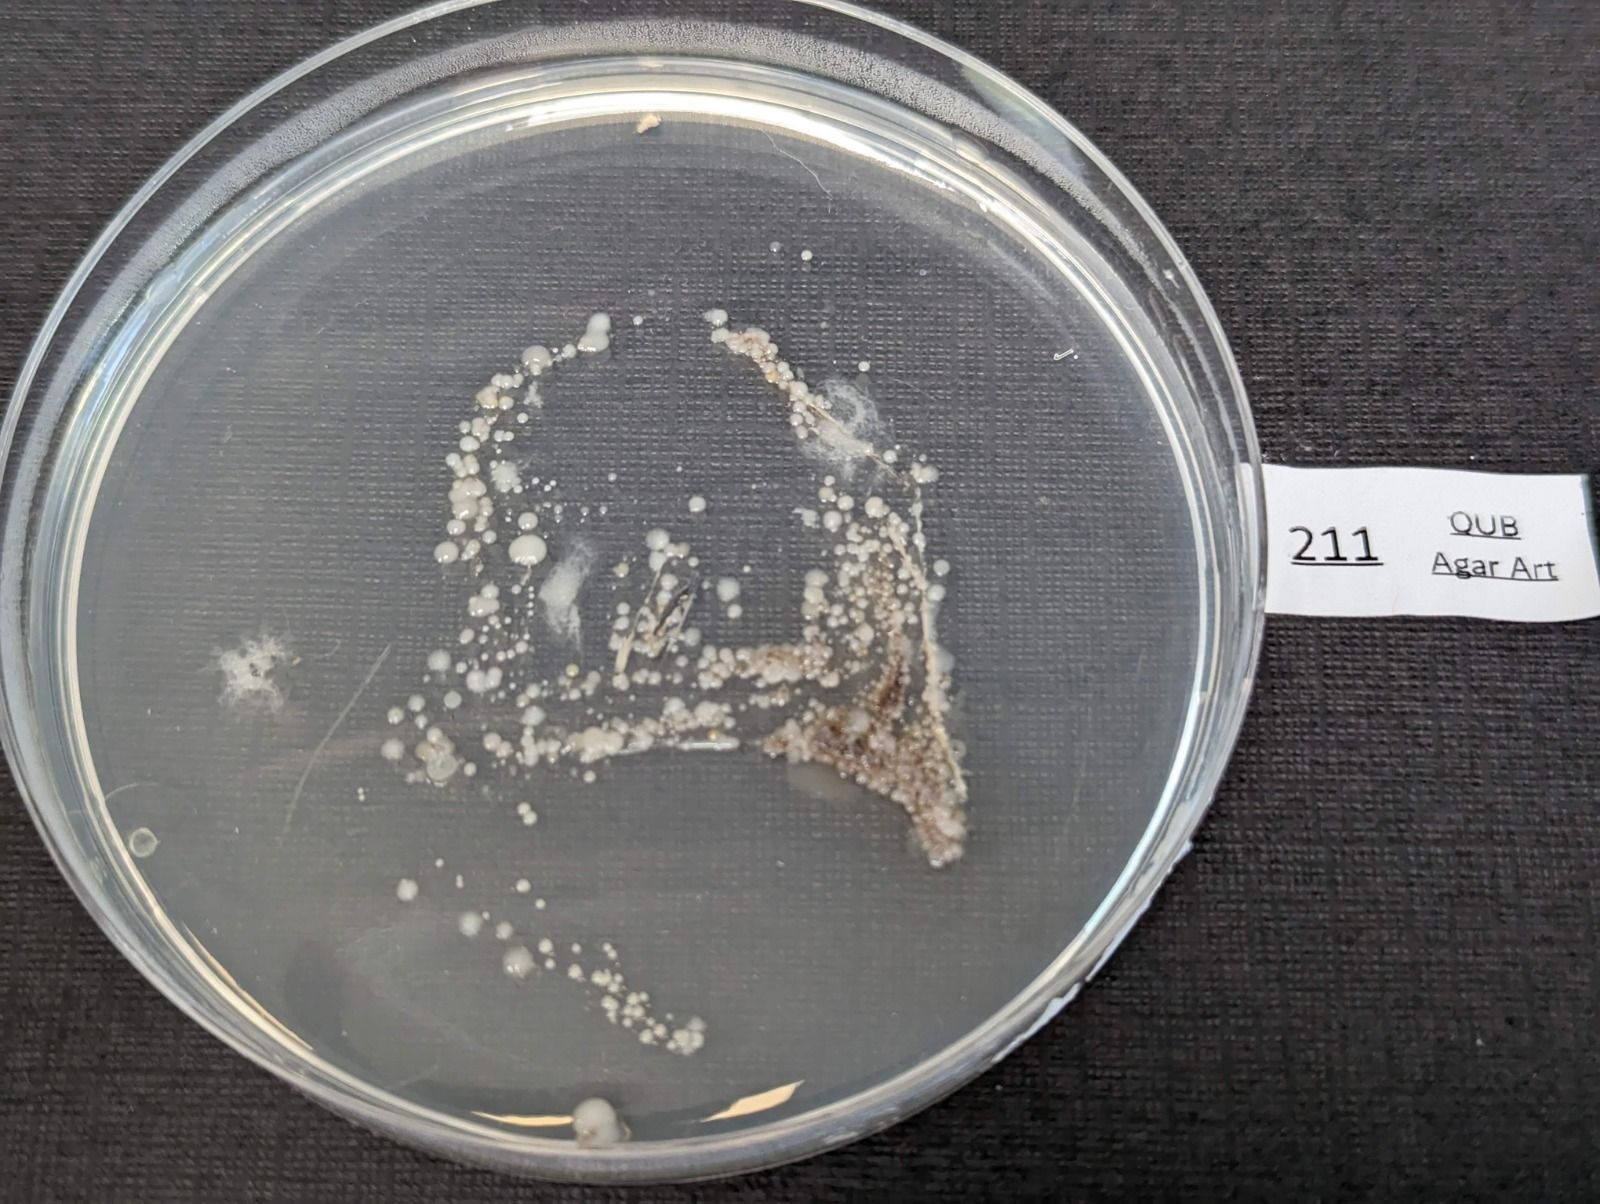
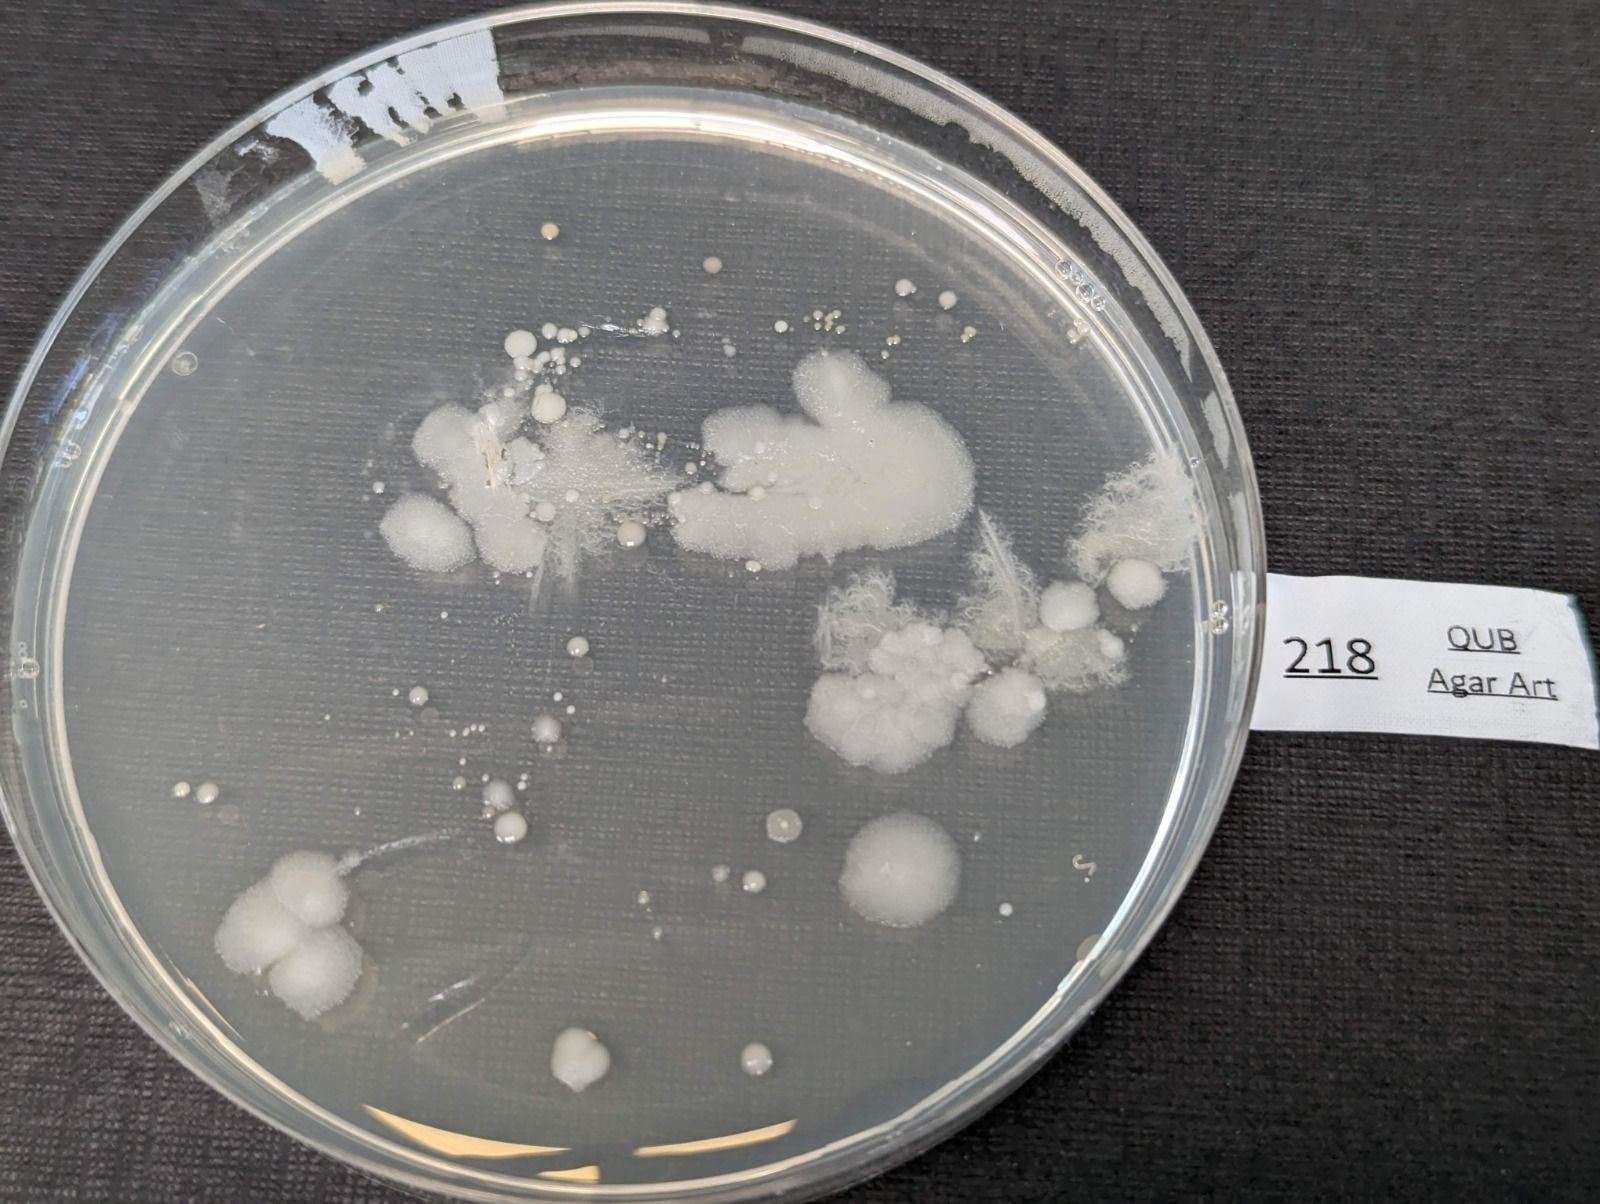
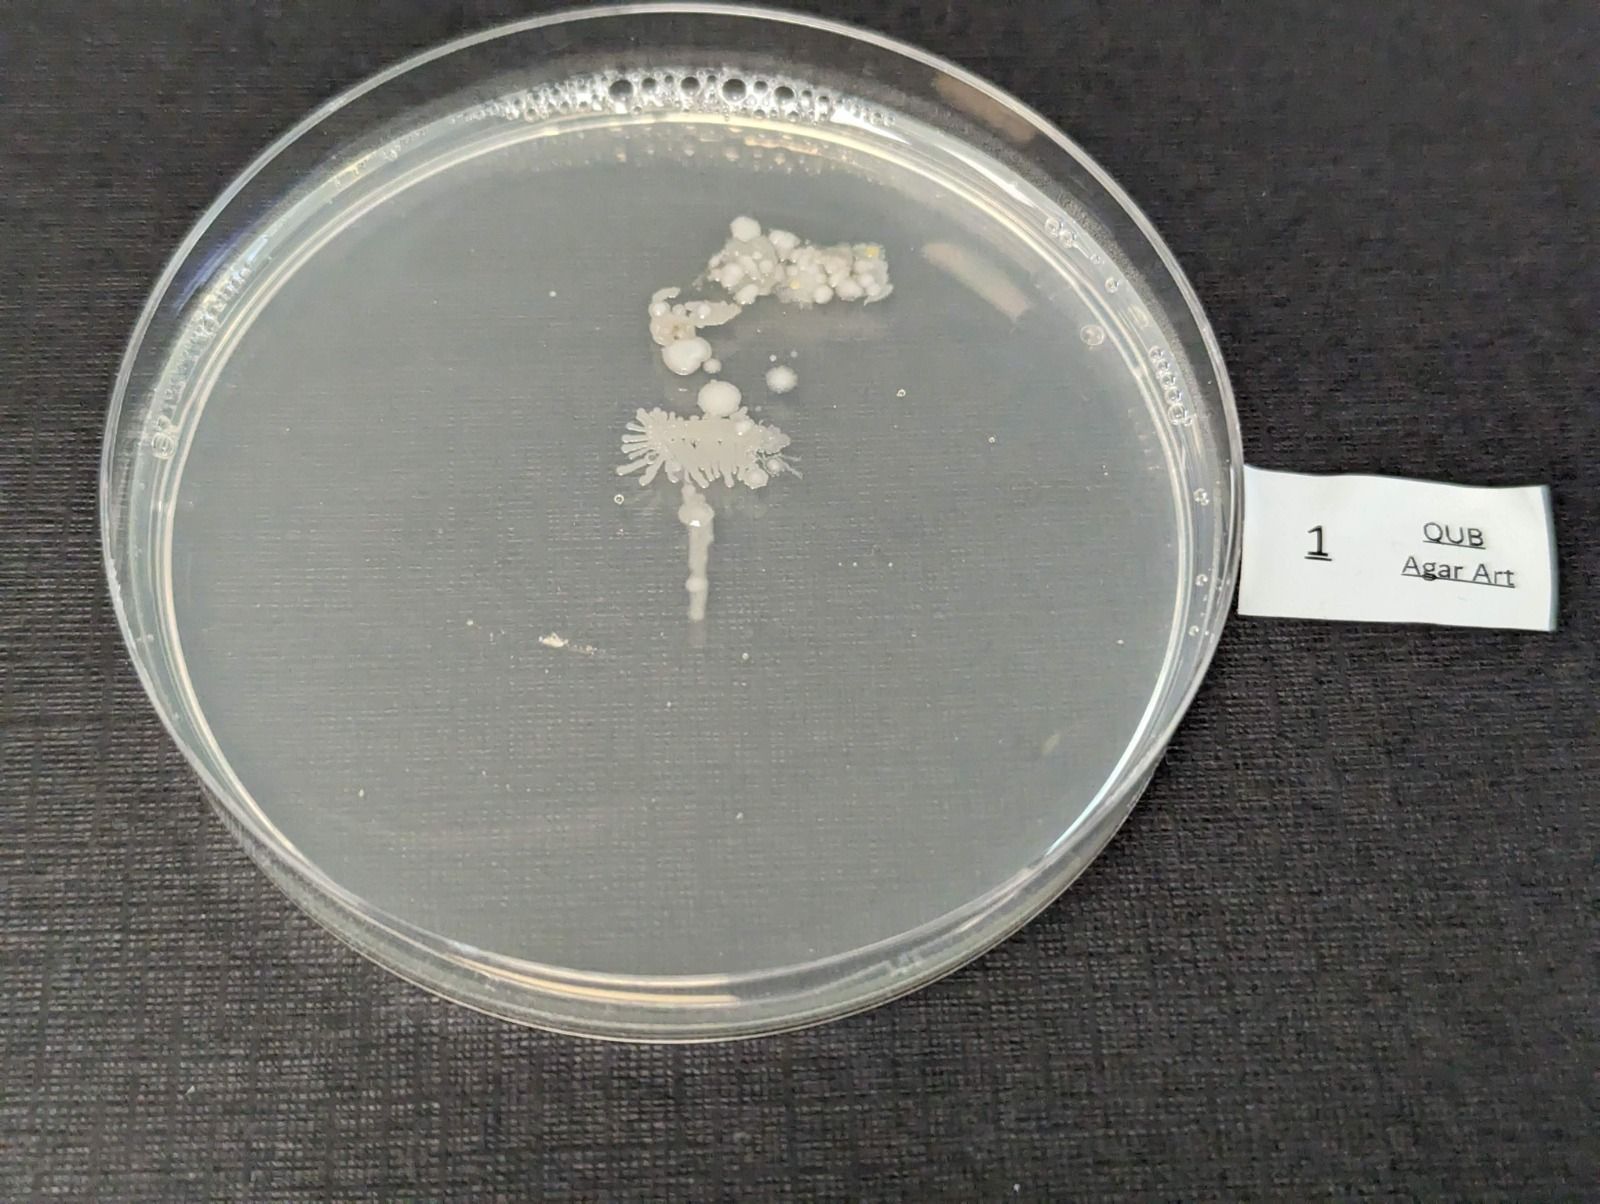

New Paragraph
Current Initiatives
BALMORAL 2023
AGAR ART COMPETITION
Winners will be contacted shortly:
1st Place: 19
2nd Place: 204
3rd Place: 8
We are sorry for the delay in uploading your plate images as we had some technical issues.
View your plates below

The Great Cart Project
Take part in our citizens' science project to understand antimicrobial resistance all around us.
Sign up to receive your kit and send us your sample

MyScience Activity
Want support for hands-on science activities at your School?
We offer a range of topical in-person and virtual sessions